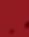

HERRINGBONE Parlour; CUBICLE Housed



SCC=194

✰ YOUNG COWS: 142 1st – 3rd Lactation
✰ CALVING: Dec-Mar (54); Apr-Jul (53); Aug-Nov (66)
✰ CLOSED HERD SINCE 2010; TB4 Area
✰ SERVICES TO: Aberdeen Angus, British Blue, Captivate, Chase, Hereford, Maddox, etc.
** Live bidding

For JE Scutt & Son (Removed from Badlesmere Court Farm, Faversham, Kent for convenience of sale)



FGBuyandSell.com AGRICULTURE’S NATIONAL CLASSIFIEDS 48-56 Auctions 57-59 Livestock 59-60 Feedstu s & Bedding 60-63 Buildings & Building Materials 65-66 Property 66 Finance Call 01772 FGBuyandSell.com SEDGEMOOR AUCTION CENTRE 01278 410250 | livestock@gth.net, NORTH PETHERTON, SOMERSET, TA6 6DF G R E E N S L A D E T A Y L O R H U N T w w w g t h n e t SEDGEMOOR AUCTION CENTRE 01278 410250 | livestock@gth.net, NORTH PETHERTON, SOMERSET, TA6 6DF G R E E N S L A D E T A Y L O R H U N T w w w g t h n e t SEDGEMOOR AUCTION CENTRE Tuesday 5th March 2024 at 11.00am The Dispersal Sale of the Milking and Incalf Heifer Portion of the NMR Herd being 186 DAIRY CATTLE Comp: 150 Dairy Cows & Heifers Inmilk &/or Incalf (Inc. 7x Swedish Red X & 2 Fleckvieh X); 26 Calved Heifers & 10 Incalf Heifers NMR HERD AV: 9570KGS. 4.18%BF 3.42%P;
on MartEye, please register in advance at gth.marteye.ie ** mccartneys.co.uk GENUINE HERD DISPERSAL SALE Upon Valued Instructions from James and Diana Moores, At LINLEY Leek Smithfield • Barnfields • Leek • Staffordshire Market Results Dairies to £2020, Cull Cows 196p/kg - £1467, Clean - £1398, Ewes £180 Lambs 370p/kg - £200, Pigs – 180p/kg - £160, Calves BB Bull £500 Store Cattle Sales 500 STORE CATTLE THIS SATURDAY 2ND MARCH 2024 Fat/Barrens: Graham Watkins 07976 370894 Dairies: Meg Elliott 07967 007049 Stores: Mark Elliott 07973 673092 Sheep: Robert Watkins 07929 946652 Visit us at www.leekauctions.co.uk Penrith Auction Mart 01768 864700 Wednesday 6th March 8am Cast Ewes and Rams followed at 10am with Prime Hoggs (Ballot 10am) Monday 11th March The Annual March Show & Sale of Top Quality Call 01772 799500 and place your ad today This week’s FG Buy and Sell starts here FGBuy andSell FGBuyandSell.com AGRICULTURE’S NATIONAL CLASSIFIEDS
s & Bedding 60-63 Buildings & Building Materials


Market Results
Dairies



Lambs 370p/kg - £200, Pigs – 180p/kg - £160, Calves BB Bull £500
Store Cattle Sales
500 STORE CATTLE
THIS SATURDAY 2ND MARCH 2024
Fat/Barrens: Graham Watkins 07976 370894
Dairies: Meg Elliott 07967 007049
SEDGEMOOR AUCTION CENTRE

01278 410250 | livestock@gth.net, NORTH PETHERTON, SOMERSET, TA6 6DF
SEDGEMOOR AUCTION CENTRE
SEDGEMOOR AUCTION CENTRE
Tuesday 5th March 2024 at 11.00am
Stores: Mark Elliott 07973 673092
Sheep: Robert Watkins 07929 946652
Wednesday 6th March
8am Cast Ewes and Rams followed at 10am with Prime Hoggs (Ballot 10am)
Monday 11th March
The Annual March Show & Sale of Top Quality Continental Store Cattle & Feeding Bulls
Entries close noon Monday 4th March
Wednesday 13th March
Sale of Store Hoggs of all classes entries close noon
Wednesday 6th March
Friday 29th March
Sale
noon Monday 18th March

01278 410250 | livestock@gth.net, NORTH PETHERTON, SOMERSET, TA6
The Dispersal Sale of the Milking and Incalf Heifer Portion of the NMR Herd being
186 DAIRY CATTLE
Comp: 150 Dairy Cows & Heifers Inmilk &/or Incalf (Inc. 7x Swedish Red X & 2 Fleckvieh X); 26 Calved Heifers & 10 Incalf Heifers
✰ NMR HERD AV: 9570KGS. 4.18%BF 3.42%P; SCC=194
✰ HERRINGBONE Parlour; CUBICLE Housed
✰ YOUNG COWS: 142 1st – 3rd Lactation
✰ CALVING: Dec-Mar (54); Apr-Jul (53); Aug-Nov (66)
✰ CLOSED HERD SINCE 2010; TB4 Area
✰ SERVICES TO: Aberdeen Angus, British Blue, Captivate, Chase, Hereford, Maddox, etc.
For JE Scutt & Son
(Removed from Badlesmere Court Farm, Faversham, Kent for convenience of sale)
** Live bidding on MartEye, please register in advance at gth.marteye.ie **
FGinsight.com | March 1, 2024 FGbuyandsell.com 48 FGBuyandSell.com AGRICULTURE’S
48-56 Auctions 57-59
Livestock
59-60 Feedstu
FGBuyandSell.com
G R E E N S L A D E T A Y L O R H U N T w w w g t h n e t
G R E E N S L A D E T A Y L O R H U N T w w w g t h n e t
mccartneys.co.uk Regulated by RICS 015 Follow us on mccartneys.co.uk Regulated by RICS 015 Follow us on mccartneys.co.uk Regulated by RICS 015 Follow us on mccartneys.co.uk Regulated by RICS 015 Follow us on GENUINE HERD DISPERSAL SALE Upon Valued Instructions from James and Diana Moores, Linley Estate At LINLEY ESTATE, LINLEY, BISHOPS CASTLE, SHROPSHIRE Comprising 120 Organic In-Calf Purebred Stabiliser Suckler Cows PD in calf to a Homebred Stabiliser Bull - Calving from beginning of April for 8 weeks On SATURDAY 9th MARCH 2024 Commencing at 12noon prompt Catalogues and Further Enquiries Craven Arms 01588 672385 / 07815 099802 Email: joanna.wall@mccartneys.co.uk Kindly Sponsored by Liquid Mineral Services (LMS) Leek Smithfield • Barnfields • Leek • Staffordshire • ST13 5PY • www.leekmarket.co.uk
to £2020, Cull Cows 196p/kg - £1467, Clean - £1398, Ewes £180
Visit
www.penrithauction.com Andrew Maughan 07717 611952 Paul Gardner 07552 589141
Auction Mart 01768 864700
us at www.leekauctions.co.uk
Penrith
of Dairy Cattle of all classes including a Special Section for Dairy Shorthorns. Entries close


Bakewell Market Results - Monday 26th February
736 Cattle & 1,503 Sheep - Full report available on our website
Store Cattle Entries for Monday 4th March
Please call the Bakewell Office on 1st March before 12 Noon Call 01629 812777
To include: Special Entry of 75 Lim Strs/Hfrs, 10-29 mnths
Watch the livestreamed cattle sales on www.streaming.auctionmarts.com
T HURSDAY LUNCHTIME WEEKLY SHEEP SALE
Entries/Enquiries, contact
Peter Oven: peter.oven@bagshaws.com or 07973 982443
Or Ivor Lowe: ivor.lowe@bagshaws.com or 07977 449126
Follow on Facebook for up to date details on Special Entries
Farm Dispersal Sales
PASTURES FARM, GAWSWORTH, MACCLESFIELD, SK11 9JB
FRIDAY 22ND MARCH 2024 AT 10:30AM
Deutz Agrofarm 420 4WD , Bobcat S175 Skid Steer c/w Attachments
Arctic Cat 700 Diesel & CF Moto 450 Petrol Quad Bikes
Mobile Foot Crush, Implements, Marshall Tanker
Cattle Equipment, Baled Silage, Straw Concrete Sleepers, Milking Parlour & Sundries
Catalogues are available to download at www.bagshaws.com

Tel: 01629 812777
Email: Deb.scholes@bagshaws.com
www.bagshaws.com


CHARTERED SURVEYORS | ESTATE AGENTS | VALUERS | AUCTIONEERS
WHITLAND MART
THURSDAY, 7TH MARCH 2024
SALE OF SUCKLER COWS, BREEDING BULLS, IN-CALVERS & BULLERS, WEANED CALVES AND PIGS. TO INCLUDE: 68 PEDIGREE LIMOUSIN COWS & CALVES, BULLING HEIFERS, IN-CALF COWS & BREEDING BULL FROM ONE VENDOR.
SALE TO COMMENCE AT 11.00 AM WITH SUCKLERS
FOLLOWED BY WEANED CALVES. PIGS TO BE SOLD AT 10.00 AM.
FOR FURTHER DETAILS, ENTIRES ETC PLEASE CONTACT
WHITLAND MART OFFICE 01994 240665
DAFYDD WALTERS 07896 605019 | DYFAN DAVIES 07812 127818
www.jjmorris.com or find us on facebook
Advertisement for the Farmers Guardian November 2023

Advertisement for the Farmers Guardian – All Marts 2024


BRIDGNORTH, CARMARTHEN & NEWCASTLE EMLYN MARTS 2024
Livestock Markets
▪ Bridgnorth, Carmarthen & Newcastle Emlyn
▪ Private & deadweight sales
▪ Primestock & store markets
Bridgnorth:
Weekly primestock sales and fortnightly store sales
Carmarthen:
Weekly dairy, calves & weanlings sales; weekly barren cows, store cattle and all classes of sheep; monthly weaned calves, suckler cows and breeding bulls; monthly orange TB restricted cattle sale; monthly Holstein South Wales show & sale
Newcastle Emlyn:

Weekly calves, weanlings, cull cows & sheep; fortnightly store cattle sales
Rural Professionals
▪ Specialising in property sales, lettings & management; dispute resolution & planning; environment al schemes & grants; valuations
Auctioneers & Valuers
▪ Growing crops & fodder; rural land & property, farm dispersal; machinery sales; annual valuations
Bridgnorth Market Contacts: Martin Clack 07977 0675198, Ollie Clack 07891 343673 or Mark Burgoyne 07831 192603
Welsh Mart Contacts: Llŷr Jones 07812 934964 or Paul Taylor 07815 509504. Bidding available on “Marteye” in Welsh marts nockdeightonagricultural.co.uk

SA33 5DR
nockdeightonagricultural.co.uk
01 267 493200
LIVESTOCK CENTRE, NANT Y CI, CARMARTHEN, SA33 5DR
LIVESTOCK CENTRE, NANT Y CI, CARMARTHEN, SA33 5DR 01 267 493200
01 267 493200
49 March 1, 2024 | FGbuyandsell.com Call 01772 799500 and place your ad today NATIONAL CLASSIFIEDS 65-66 Property 66 Finance 66 Motors 67-75 Tractors & Machinery For all our careers adverts, see our careers special! Call 01772 799500 and place your ad today TM ONLINE MACHINERY SALE CLITHEROE AUCTION MART www.auctionmart.co.uk • T:01200 423325 Jeremy: 07815 727993 • George: 07412 165873 HORSES & TACK SALE WEEKLY PRIMESTOCK SALE Saturday 2nd March 10am Monthly Horse & Tack Sale of 700 Lots of Tack, Saddles, Rugs & 30 Horses Tuesday 5th March 12.30pm Prime Hoggs & Cull Ewes FORTNIGHTLY STORE CATTLE SALE + CALVES/ STIRKS Thursday 7th March 12.30pm Sale of young Bulls, Store Heifers & Steers. Rearing calves 12 noon Thurs 21st - Sat 23rd March Intake of items from Tues 5th –Thurs 14th March Monthly Sale of Sheep with Lambs at foot, In-lamb Ewes, Geld Hoggs & Goats Saturday 9th March 10am Further entries accepted on the day. Advertisement for the Farmers Guardian November 2023 nockdeightonagricultural.co.uk LIVESTOCK CENTRE, NANT Y CI, CARMARTHEN,
**********************
***********************
The Livestock Auctioneers Association The industry shop window CONTACT YOUR LOCAL LIVESTOCK MARKET AT www.laa.co.uk
VIEW FROM THE ROSTRUM
Trade begins to strengthen
Meg Elliott on the rise in prices for stock
After a steady start to the year, the trade for dairy cows through February has continued to harden, with the best yet again tipping the £3,000 mark.
What has changed, you might ask, to explain the increased buoyancy. The answer is not a great deal.
While there has been a slight increase in the milk price in the New Year, this would not be considered a significant improvement with the average payment for February remaining in the 37-39ppl price bracket.
However, the trade has gone from what can only be described as lacklustre and quite fickle to strong for all classes and quality.
Through January, cow prices were unpredictable. One week you could have a bouncy trade for all qualities and the next a much steadier affair, with second- and third-rated animals

being particularly hard to place. Since the beginning of February, the task of selling has become a more pleasurable experience, which began with the lesser end being considerably more keenly sought after.
On Tuesday at Leek, a bumper entry of 133 sold on an exceptional trade which saw all classes including in-calf heifers and youngstock making good money. First quality heifers were all in
TIMED ONLINE AUCTION OF 2NO. FENDT TRACTORS, SPRAYER, DEWULF POTATO HARVESTER, POTATO GROWING EQUIPMENT, IMPLEMENTS & MACHINERY

To include: Tractors: 2015 Fendt 936 Vario (10,244hrs), 2014 Fendt 724 Vario (11,150hrs).
Loader: 2000 Matbro TM250-R (10,376hrs). Self-propelled Potato Harvester: 2020
Dewulf DS30P40-50 (2,336hrs). Self-Propelled Sprayer: 2021 Fendt Rogator 655 36m
Potato Equipment: 2021 Dewulf DS30P40-50 planter, 2021 Scanstone 3845HDAR ridger, 2020 Jones 16t Rootcrop field loader chaser, 2006 Grimme GT170S harvester, Reekie haulm topper. Irrigation: Briggs R50/R64 booms, 1992 Perrot TRS 110/300 reel.
Machinery: Kongskilde Delta 5m and Lemken Smaragd cultivators, Weaving combination cultivator drill 3.5m, 2008 Kuhn VKM305 flail mower, 2010 Jones carrot crowner, Cousins V-Form, Cousin Patriot, 2004 Lemken Euro Diamant 7f plough. Trailers: Bye Engineering fifth wheel, 2008 Bailey 14t 2005 AC 14t and 1983 Richard Western 10t trailers, 2005 Montracon curtain sider, Chieftain 1,000ltr bowser. Also: conveyors, cultivators, trailers, weights, farm vehicles, wheels, tyres and associated spares. Included by Permission: Simba DTX 300, Teagle Multidisc 250XL, 2015 Kuhn 3m combination drill, Jones 1500 onion windrower, CTM Rockstar de-stoner, Garford Robocrop, Stanhay 12row onion drill
COMMENCES: THURSDAY 7TH MARCH 2024 AT 9.00AM
FINISHES: THURSDAY 14TH MARCH 2024 AT 10.00AM
VIEWING DAY: FRIDAY 8TH MARCH 2024 FROM 10.00AM - 4.00PM
that £2,500-£3,000 price bracket, with 23 passing the £2,000 mark.
The quality of animals presented



On a week-by-week basis, numbers of milkers forward nationally are down and, as of yet, there have been few herd dispersals and, in all likelihood, are there likely to be many.
One would argue that we have sold so many herds in the last decade that they are simply not there to disperse.
Those in milk production now are generally wanting to stay in it and, other than retirements, the reasons for a herd dispersal are only likely to result from death, divorce or tragedy.
Although the weather has not been kind, we are heading into the spring which often results in a more optimistic clientele and consequently trade.
All of these factors influence prices now and going forward and as ‘turning out time’ draws ever closer










Auctions | March 1, 2024 50 FGBuyandSell.com XX | MARCH 1 2024
cheffins.co.uk 01353 777767 onsite@cheffins.co.uk
Meg Elliott at the rostrum.
On instructions from W.O. & P.O Jolly due to to a change in farming policy ROUDHAM FARM, ROUDHAM, NORWICH, NR16 2RJ To register and view all current auctions please visit our website TEL: 01226 247591 www.wattsauctions.co.uk Watts & Associates Barkston Road, Carlton , Barnsley. S71 3HU Browse. Sell. Buy at FGBuyandSell.com A New Route to Market

BORDERWAY MART, CARLISLE
Tel: 01228 406200
Show and sale of 800 CONTINENTAL
CROSS STORE CATTLE
Evening Show Friday 1st March – 6.00pm
Sale Saturday 2nd March – 9.00am
Kindly sponsored by Sponsored by AW Jenkinsons, Tynedale Farm Supplies, Tithebarn & R&J Mulholland Butchers
STORE HOGGS also BREEDING SHEEP & INLAMB EWES
Monday 4th March – 11.00am
Sale to include 300 inlamb Texel/Blackface/ Cheviot ewes various ages due start April from M/S Hastings, Lockwood Farm Please advise entries Joe Bowman 07736 883670
– Rory Livesey 07535 001541
225 DAIRY CATTLE SELLING AT BORDERWAY
BORDERWAY MONTHLY DAIRY DAY
Wednesday 6th March 2024 - 10.30am
Comprising: 175 freshly calved cows/heifers40 In-calf heifers - 10 bulling heifers
Breeds represented include Holstein Friesian, Jersey, British Friesian, Fleckvieh & Ayrshire
FRESHLY CALVED ANIMALS The sale includes: Another outstanding consignment of freshly calved cows and heifers all producing large volumes of milk from many of the top dairy farms in the North.
LARGE CONSIGNMENTS Other consignments of freshly calved animals include CLACKMAE (14)
WREAYWOOD (12) KIRTLEBANK (10)
GUILLYHILL (10)
JERSEYS the Kerricks pedigree Jersey herd have consigned 40 heifers comprising 20 freshly calved heifers and 20 In Calf heifers due soon to top sexed sires. This is an exceptional group! The Kerricks herd is one of the top production herds in the UK.
IN CALF HEIFERS 20 pedigree Jersey in calf heifers sell 20 Holstein Friesian in calf heifers sell due soon
YOUNGSTOCK a special batch of bulling heifers PLEASE ORDER YOUR CATALOGUE TODAY or connect with someone from the sale staff.
PLEASE FOLLOW US ON FACEBOOK TO VIEW ANIMALS PRIOR TO THE SALE
500 STORE CATTLE
Wednesday 6th March – 10.00am
Special sale of YOUNG BULLS
Prizes for top price single bull under 12mths and 12mths and over Pens of 3 or more under 12mths and 12mths and over
WEANERS & YOUNG BULLS – 12.30pm
YOUNG CALVES – 10.00am
Show and sale of
PEDIGREE HOLSTEIN FEMALES
Wednesday 20th March
On behalf of Border & Lakeland Holstein Club Entries close Wednesday 6th March
Show and sale of PEDIGREE HOLSTEIN & BRITISH FRIESIAN BULLS
Wednesday 10th April
On behalf of Border & Lakeland Holstein Club
Entries close Wednesday 13th March
Show and sale of PEDIGREE LIMOUSIN CATTLE
Friday 3rd /Saturday 4th May
Entries close Monday 4th March
PEDIGREE BEEF DAY
Friday 10th & Saturday 11th May
Shows and sales of CHAROLAIS CATTLE
Including the “White Gold” show and sale of all classes of females
BRITISH BLUE CATTLE
on behalf of Border British Blue Club
BLONDE CATTLE, SIMMENTAL CATTLE & SALER CATTLE
Entries close Friday 15th March
ONLINE SALE
SALE OF MACHINERY, IMPLEMENTS & HEAVY PLANT items
Sale bidding starts 10.00am
Wednesday 6th March
until 10.00am Thursday 7th March
Sale includes Dispersal sale of Farm Machinery, Equipment & Small Tools on behalf of Robin Hood Farm, Bassenthwaite CA12 4RJ
On Farm Viewing of lotsSaturday 2nd March 11am - 3pm
KIRKBY STEPHEN MART
Tel: 01768 371385
Monday 4th March
Show and sale of 360 STORE CATTLE
Also 60-70 cast/feeding cows & OTM cattle also Special spring sale of 80 BEEF BREEDING CATTLE
To include part dispersal of 14 pure Limousin cows & heifers with calves at foot from Messrs Porter, Low Oxnop Judging 8.45am -
Sale Commencing with Cast Cows 9.30am followed by Beef Breeding Cattle and Store Cattle
MIDDLETON MART
Tel: 01833 640281
STORE CATTLE
Tuesday 12th March
Entries close 10am Monday 4th March
H&H Group plc (H&H) SALE OF 4901 SHARES OF £1 EACH IN H&H GROUP PLC BY AUCTION
Wednesday 6th March 2024 at 12.00 noon
In Ring 1 at Borderway Mart, Carlisle
SALE OF 2175 SHARES OF £1 EACH IN H&H GROUP PLC BY AUCTION
Thursday 14th March 2024 at 10.30 am
In the ring at St Boswells Auction Mart
If you are unable to attend the auction you can make alternative arrangements to purchase shares either by phone or by leaving commission bids with Margaret Irving on 01228 406334, 07912 485326 or margaret.irving@hhgroupplc.co.uk
Please note that copies of the Annual Report for the period to 30th June 2023 and Interim Report to 31st December 2023 will be available on our website at http://hhgroupplc.co.uk/share-news/
Please note that only existing shareholders or restricted investors will be permitted to bid for these shares. If you are Interested in purchasing shares you should contact Margaret Irving to establish whether they meet the eligibility criteria under relevant legislation. Investments in shares are for the long term. The value of your investment and the income derived from it can go down as well as up and you may get back less than you originally invested.
If you are in any doubt about purchasing shares, you should consult an independent financial advisor author-ised under the Financial Services and Markets Act 2000. This financial promotion has been approved by SPARK Advisory Partners Limited (“SAPL”) under s21 of the Financial Services and Markets Act. SAPL is authorised and regulated by the Financial Conduct Authority. SAPL makes no recommendation as to the suitability of shares in H&H Group plc as an investment.



51 March 1, 2024 | FGbuyandsell.com Call 01772 799500 and place your ad today FARMSTOCK AUCTIONEERS, BROKERS & VALUERS PLEASE SCAN TO VIEW OUR ONLINE CATALOGUES Visit www.harrisonandhetherington.co.uk or follow us on Facebook & Instragram
NORTH WEST AUCTIONS
LIVESTOCK AUCTIONEERS � VALUERS
www.nwauctions.co.uk info@nwauctions.co.uk
LANCASTER AUCTION MART
Tel: 01524 63308
Monday 4th March
10.30am PRIME HOGGS & CAST SHEEP
11.30am OPENING WEEKLY SALE OF SHEEP WITH LAMBS AT FOOT
Friday 8th March
10.15am 150 REARING CALVES & WEANLINGS
10.15am 150 CAST / OTM CATTLE
11am DAIRY CATTLE
11.15am 300 STORE CATTLE
J36 RURAL AUCTION CENTRE
Tel: 015395 66200
Tuesday 5th March
1pm 2000 PRIME HOGGS & CAST SHEEP

BARNARD CASTLE AUCTION MART
TUESDAY 5TH MARCH
20-25 OTM Cattle
25 Feeding Bulls & 150 Store Cattle
Sale at 10am
PATELEY BRIDGE AUCTION MART
TOMORROW SATURDAY 2nd MARCH
Sale of 30 OTM, Prime & Cattle
Prize Show & Sale of 35 Feeding Bulls Sale of 115 Store Cattle
Sale at 11am
BROUGHTON AUCTION MART
Please note the next sale will be the April Fair
SATURDAY 20TH APRIL
Prize Show & Sale of Feeding Bulls & Store Cattle
Sale at 11am
Early entries appreciated
www.barnardcastleauctionmart.co.uk
Libby Bell Auctioneer on 07818 435728




Thursday 7th March
SHOW & SALE OF STORE CATTLE (Under 12 Months)
Predominately TB4, Homebred Cattle. Buyers attendance highly recommended.
10am 150 REARING CALVES & WEANLINGS
10.30am 100 CAST / OTM CATTLE
11.15am 500 BEEF BREEDING, STIRKS & STORE CATTLE
Tuesday 12th March
11am OPENING SALE OF SHEEP WITH LAMBS AT FOOT
Thursday 14th March 10.30am
Fortnightly Sale of IN LAMB SHEEP & 1000 STORE HOGGS
ONLINE MACHINERY SALES
Delivery: Monday 4th & Tuesday 5th March
Sale to Commence: Friday 8th March
Viewing: Friday 8th (9am-4.30pm) & Saturday 9th (am only)

...Yorkshire’s Friendly Mart
SATURDAY 2ND MARCH
150 Breeding & Store Cattle of all classes inc
2 Lim Hfrs, 10mths, I Wilkinson
16 Lim Hfrs, 10-13mths, S & P Padfield
19 Limx strs & hfrs,11-12m, Spencer & Fox
5 Lim/SimX Strs, 12mths, Riby Grange
3 B Galloway Cows in calf to B Galloway, Dalton Park
2 Lim Bulls10-11mths, P Oxley
4 Lim Hfrs 11mths, J & L Cardwell
10 Blonde AquitaineX Hfrs, 12-15mth, R Burton
4 AAx bulls, 11-12m, K Terry
2 AA Bulls, 9mths, B Brook
Store & Breeding Sheep inc
120 Store & Breeding Pigs Pigs 9am Sheep 9.45am Cattle 10.45am
Contact Office for Details
MART OFFICE: 01757 703347
WEDNESDAY 6TH MARCH
RICHARD HAIGH: 07768 594535
400 Prime Cattle 410 Prime Sheep 175 Prime Pigs Pigs 9am Sheep 9.45am Cattle 10.30am
www.selbymart.co.uk
Contact Office for Details
MART OFFICE: 01757 703347
RICHARD HAIGH 07768 594535
www.selbymart.co.uk

Monday 4th March
SALE OF REARING CALVES Sale 10.30am
PRIME, CAST & FEEDING CATTLE Sale 11.30am (TB exempt section available) MONTHLY SHOW & SALE OF PRIME HOGGS Sale 12.30pm followed by CAST EWES
Weekly Sale of INLAMB EWES, EWES WITH LAMBS at FOOT & STORE SHEEP Sale 11.30am (Entries to the office by Friday for Online Catalogue)
Monday 11th March
Early SHOW & SALE OF EWES WITH LAMBS AT FOOT
Wednesday 13th March
Sale of FEEDING BULLS, PRIME CATTLE, BEEF FEEDING COWS, STORE & BREEDING CATTLE
Inc MONTHLY PRIME CATTLE SHOW (Entries close Wednesday 6th March)
Saturday 16th March
LIVESTOCK ONLY SALE 250-300 STIRKS, WEANED/SUCKLED CALVES, BREEDING & CULL GOATS, STORE & BREEDING SHEEP (ent by Monday 11th March)
Dairy Cattle
Monday 4th March
Show & Sale of 15-20 DAIRY CATTLE Sale 12noon
Monday 18th March
Show & Sale of DAIRY CATTLE
Monday 1st April
Spring Dairy Youngstock Spectacular for pedigree and commercial heifers
Monday 15th April
Spring Coloured Breeds Sale of in milk and youngstock
Further details to follow, register your interest to both buy and sell soon for planning and advertising with Sarah on 07710 795585
Working Sheep Dogs
Tuesday 12th March
ONLINE TIMED AUCTION OF WORKING SHEEPDOGS
(Entries close Tuesday 5th March)
FGinsight.com Auctions | March 1, 2024 FGbuyandsell.com 52 FGBuyandSell.com The Livestock Auctioneers Association The industry shop window CONTACT YOUR LOCAL LIVESTOCK MARKET AT www.laa.co.uk
AUCTION MART Tel: 01756 792375 www.ccmauctions.com
Jeremy Eaton - 07747 780481 Ted Ogden - 07855 958211 Kyle Hawksworth - 07538 539077 Rob Cloughton 07496 278828
SKIPTON
Auctioneers:
- - - - - - - - - - - - - - - - - - - - - - - - - - - - - - -
- - - - - - - - - - - - - - - - - - - - - - - - - - - - - - -
- - - - - - - - - - - - - - - - - - - - - - - - - - - - - - -

FRIDAY 8TH MARCH – 11.30AM
EXETER LIVESTOCK CENTRE, EXETER, DEVON EX2 8FD SALE OF 120 DAIRY CATTLE
THE ENGLISH GOLD TOP SALE OF 50 PEDIGREE JERSEYS
Comprising: 20 Freshly Calved Holstein Friesian Cows & Heifers from local vendors. Sale of 51 Pedigree Holstein In Calf, Bulling & Yearling Heifers from the 12,027Kgs Morchard Herd of Messrs Yendell, Crediton. The Gold Top Sale of 50 Jerseys to inc the Dispersal Sale of the Newventure & Princesstillstar herds of 42 head on behalf Messrs TS & M Oaks of Worcester. The herd is exceptionally well bred from great families inc Belle, Birch, Cyber, Melba, Grove & Nouvelle. The herd includes 19 In Milk and/or In Calf Cows & Heifers, 11 In Calf & Served Heifers & 12 Maiden Heifers. Plus youngstock from the Riverview herd.

Brockholes Arms

Auction Mart
Claughton On Brock, Preston PR3 0PH
01995 640280 www.garstangmart.co.uk
GISBURN AUCTION MARTS Auctioneers, Valuers, Agents
Tom Greenow - Market Manager 01200445376
Rachel Capstick 07713075659
Jack Pickup 07710708326 Eleanor O’Neill 07706347505
Matthew Middleton 07860659803
Saturday 2 March
9.30am WEEKLY CAST SHEEP & PRIME HOGGS
Enquiries to Tom Greenow or the office this week
1025+
HEAD
10.30am 221 OUTFITS OF SHEEP & LAMBS AT FOOT followed by 351 IN LAMB SHEEP 12.30pm 251 STORE HOGGS catalogue online. Enquiries to Rachel
Tuesday 5 March
MONTHLY MACHINERY SALE 10am
All entries to the yard Monday 4th 8am to 2pm strictly - loadall onsite. Catalogue online Monday Evening. Known entries of: Leyland 270 with loader, 1t portable proven hopper, 5’6” loader bucket, Muck grab, 1300gal tanker Ifor livestock trailer, hiSpec Feeder, Feed Troughs, Lambing Equipment, hang on cattle troughs, Feed Barriers, workshop clearance, Lamb adopters, fencing misc., gate and hurdles.
Thursday 7 March
10.30am PRIME BEEF followed by CULL CATTLE
10.30am REARING CALVES


11.00am DUGDALE NUTRITION with LELY SHOW & SALE OF DAIRY entries please by Monday 4th 4pm
Saturday 9 March
9.30am WEEKLY CAST SHEEP & PRIME HOGGS

Auctioneer: Ian Atkinson 07944 237516

Tuesday 5th March, 2024
9.00 a.m. 750 Prime Hoggs & 180 Cast Ewes/Tups
10.30am Opening Sale of Sheep with Lambs at Foot 25 Mule & Cont Ewes & Lambs Entered
10.30 a.m. Sale of 100 Store Cattle
11.30 a.m. 60/80 Rearing Calves, Weanlings & Stirks
Wednesday 6th March, 2024
10.30 a.m. OTM Sale & TB Exempt Cattle
Wednesday 27th March, 2024
12noon Show & Sale of Dairy Cattle
Entries close 21st March

Tuesday 5th March
1500 Prime Hoggs
300 Cast Ewes
10.00am BREEDING & STORE CATTLE
10.30am SHEEP WITH LAMBS & IN LAMB SHEEP
Entries please for both catalogues by Tuesday 5th 12noon
Thursday 14 March
10.30am PRIME BEEF followed by CULL CATTLE
10.30am REARING CALVES
12.30pm STIRKS Entries please by Tuesday 5th 12noon
Saturday 16 March
9.30am WEEKLY CAST SHEEP & PRIME HOGGS
10.30am SHEEP WITH LAMBS, IN-LAMB, STORES
Friday 22 March – Saturday 23 March
Culmination of the Young Handlers Overwintering 23-24 event. The show will be held at 6pm on the Friday evening, spectators welcomed to support our next generation, light refreshments served in the café. All animals will be sold as part of the Store Cattle sale on Saturday 23 March. Catalogue available that week.
www.gisburnauctions.com | 01200 445376

10am
Saturday 9th March
Spring Show & Sale of Store Cattle, Beef Breeding & Cull Cattle.
Tuesday 12th March
In-Lamb Ewes & Gimmer Hoggs (Please Enter) Telephone: 01969 667207, 015396 20895, 07974 126397. 07711 469280

Monday 4th March
Usual Fatstock Sale

Saturday 9th March 10.30am
Machinery & Sundries Sale
Drop items off Friday 12 – 2.30pm Or Sat from 7.30am
Approx 45 Acres of Summer Grazing
Felliscliffe area – Cattle/Mowing Ring Ian for details
Ian Smith - Mart Manager 07738043771
Office 01943 462172 wfam@auctionmarts.com

Auctions 53 March 1, 2024 | FGbuyandsell.com Call 01772 799500 and place your ad today The Livestock Auctioneers Association The industry shop window CONTACT YOUR LOCAL LIVESTOCK MARKET AT www.laa.co.uk We take a farmercentric approach to media. Our job is to help farmers run their farms more efficiently and make better purchasing decisions
HAWES, NORTH YORKSHIRE, DL8 3NP
at
&
Rams

WEEKLY SALES
PRIME SHEEP
Every Thursday at Thrapston
STORE & BREEDING SHEEP & CATTLE, CALVES, PIGS & GOATS
Every Saturday at Thrapston
ALL CLASSES OF SHEEP & PRODUCE
Every Tuesday at Stratford
Thrapston Livestock Market
Saturday 2nd March
Smallholders Sale
To include: Goats, Pigs & Sundries
No pets can be sold, due to our local Councils instructions. Please contact us for further information
Machinery & Other Sales
Friday 22nd March
A Dispersal Sale of Game Rearing Equipment at Rampton, Cambridgeshire
The sale is being held due to the retirement from the business. They previously hatched and reared over 30,000 chicks.
The sale is to include NEW and USED heaters, feeders, drinkers, penning, housing and incubators.
Further comprehensive details will be in the catalogue. If you would like a hard copy, please contact the office or visit our website.
Reduction Sale
Starts Wednesday 27th March, at 12 noon
Finishing Tuesday 2nd April, from 12 noon
An Online Auction of Agricultural Machinery and Effects
At Ellas Farm, Loughborough
Briefly to include: Farm Machinery, Cattle and Sheep Equipment. Further details will be on our Online Auction Site and social media
For further information contact:
Alastair Brown: 07885 804450
Jake Wagstaff: 07487 526803 01832 732241 or visit the website for weekly listings of sale entries
The Livestock Auctioneers Association

BENTHAM AUCTION MART

015242 61444 - Sale Days 61246
Stephen 07713 075 661
Greg 07713 075 664
Will 07590 876 849 www.benthamauction.co.uk
Tuesday 5th March
10.30am 40-50 Feeding & Cast Cows & OTM Cattle
325
Inc. Annual Consignment from J & I Whitaker, Bowsber 15 Lim x / BB x Beef Bred Bulling Hfrs 18-24m
Wednesday 6th March
11.30am 75-100 SHEEP WITH LAMBS AT FOOT
2.30pm 2000 Cast Ewes followed by 2500-3500 Prime Hoggs
Tuesday 12th March
In Lamb Breeding Sheep Fortnightly Sale of Store Hoggs Entries for catalogue close Friday 1st March
Wednesday 13th March Fortnightly Sale of Dairy Cattle
Tuesday 19th March
March Show & Sale of FARMERS STIRKS & YOUNG STORES
Wednesday 20th March
Easter Spring Lamb Show & Supreme Hogg Competiton
Saturday 23rd March
Spring Collective Sale of Farm Machinery & Equipment Entries Invited. Contact Will on 07590 876849
Richard Turner & Son

THE 93rd MIDSHIRES PRODUCE AUCTION. Approx 4,500 Tonnes on Farms and Estates in the Central Midland Counties
To include a comprehensive selection of HAY, STRAW, HAYLAGE, SILAGE & FODDER BEET in all sizes, easily accessible to towns including Coventry, Leicester, Lutterworth, Market Harborough, Northampton, Nuneaton, Rugby and Southam.
Together with:
200 Tonnes Maize Silage at Sapcote, Leicester, 80 Tonnes Grass Silage at Wormleighton, Southam, 50 Tonnes Fodder Beet at Ansty, Coventry, 100 Tonnes Crimped Maize at Kenilworth, Coventry Plus: Hay and Straw for delivery.
TO BE SOLD BY AUCTION ON Tuesday 5th March 2024 at 2.30pm. Lutterworth Rugby Football Club, Ashby Lane, Bitteswell, Lutterworth, Leicestershire LE17 4LW (3 Miles from Junction 20 of the M1 Motorway)
ASHLEY WALLER AUCTIONEERS
HORTICULTURE
9.30am Every Wednesday and from 7th March 5pm every Thursday evening Entries include bare rooted trees, shrubs, bedding plants, logs etc..
FURNITURE Next Sale 13th & 14th February
PRODUCE Every Monday at 12.30pm
MACHINERY
Next Sale Tuesday 12th March - Entries already include New Holland 6030, Kuhn SC314D Mower, Keenan MechFIBER 320 Feeder Wagon. Timber Wolf Shredder, Apache Quad. (Last sale 1764 lots)
info@ashleywaller.co.uk www.ashleywaller.co.uk www.easyliveauction.com
The industry shop window
CONTACT YOUR LOCAL LIVESTOCK
MARKET AT www.laa.co.uk
Catalogues & Information Tel: 01788 564749 7 – 11 Albert Street, Rugby, CV21 2RX www.howkinsandharrison.co.uk/auctions
PEDIGREE LIVESTOCK SE R V ICES LIMITE D
We specialise working in partnership with Livestock Societies providing a bespoke support service.
SUPPORT – we can support recognised Livestock Societies with their day to day administrative work and support.
We specialise working in partnership with Livestock Societies providing a bespoke support service.
SUPPORT – we can support recognised Livestock Societies with their day to day administrative work and support.
catalogue work, promotions, equine passports, meeting and event support.
DELIVER – we can deliver and assist with your requirements as we offer over 150 years combined experience in the livestock and agricultural industry.
DELIVER – we can deliver and assist with your requirements as we o er over 150 years combined experience in the livestock and agricultural industry.
MANAGE – we can manage everything from administrative support, registrations, annual publications, catalogue work, promotions, equine passports, meeting and event support.
MANAGE – we can manage everything from administrative support, registrations, annual publications, catalogue work, promotions, equine passports, meeting and event support.
Holme House, Dale, Ainstable, Carlisle CA4 9RH
07801 868856 e: info@pedigreelivestockservices co.uk
pedigreelivestockservices co.uk
FGinsight.com Auctions | March 1, 2024 FGbuyandsell.com 54 FGBuyandSell.com
Chartered Surveyors, Estate Agents, Auctioneers & Valuers Tel: 01538 373308 Email: enquiries@grahamwatkins.co.uk www.grahamwatkins.co.uk BI-ANNUAL COLLECTIVE SALE SATURDAY 23RD MARCH 2024 HEATH HOUSE FARM, CHEDDLETON, NR LEEK, STAFFORDSHIRE, ST13 7DQ SALE TO INCLUDE Tractors, Vehicles & Machines Usual Range of Implements, Trailers, Builders & Contractors Equipment. Usual Wide Range of Plant & Livestock Trailers Usual Range of New & Used Livestock Equipment, Fencing Equipment, Range of Small Tools Sundry Farming & Building Effects etc ENTRIES NOW INVITED SALES PHONE 07375 105985
THRAPSTON STRATFORD www.bletsoes.co.uk
AUCTIONEERS VALUERS & ESTATE AGENTS Est 1803
RTS
STORE CATTLE
BULLING HEIFERS
&
11am 100-150 REARING CALVES
PEDIGREE LIVESTOCK SE R V ICES LIMITE D specialise working in partnership with Livestock Societies providing a bespoke PEDIGREE LIVESTOCK SE R V ICES LIMITE D Holme House, Dale, Ainstable, Carlisle CA4 9RH t: 07801 868856 e: info@pedigreelivestockservices co.uk www.pedigreelivestockservices co.uk We specialise working in partnership with Livestock Societies providing a bespoke support service. SUPPORT – we can support recognised Livestock Societies with their day to day administrative work and support. DELIVER – we can deliver and assist with your requirements as we o er over 150 years combined experience in the livestock and agricultural industry. MANAGE – we can manage everything from administrative support, registrations, annual publications,
t:
www.




































55 March 1, 2024 | FGbuyandsell.com Call 01772 799500 and place your ad today SIMULTANEOUS ONLINE BIDDING ALSO AVAILABLE ON SIMULTANEOUS ONLINE BIDDING ALSO AVAILABLE ON FARMERS’ SPRING MACHINERY SALE CLOSED FOR SMALLER LOTS BICKER BAR, BOSTON, LINCOLNSHIRE, PE20 3AL 23rd MARCH 2024 SATURDAY By instructions from C Tomlinson Ltd - Following the sale of the farm. DISPERSAL AUCTION DISPERSAL AUCTION View Day: Friday 15th March 2024 at 12 noon to 4pm SATURDAY 16thMARCH - 10am BLEAK HOUSE FARM, NORTH KYME DROVE, LINCOLNSHIRE LN4 4DE www.willbarker.co.uk lincslandagent WillBarkerandCo info@willbarker.co.uk 01529 414555 By instructions from JW Grant Ltd - whilst restructuring the business. FRIDAY 31st MAY & SATURDAY JUNE 1st 2024 FOLD HILL, OLD LEAKE, BOSTON PE22 9PJ

FGinsight.com Breed Societies | March 1, 2024 FGbuyandsell.com 56 FGBuyandSell.com Scottish Auctions T: 01556 502 381| W: www.walletsmarts.co.uk | E: walletsmarts@auctionmarts.co.uk WALLETS MARTS CASTLE DOUGLAS LTD FOR ANY ENQUIRIES, PLEASE CONTACT Bruce Walton 07711 299677 John Smith 07771 506025 Auction Mart, New Market Street, Castle Douglas DG7 1HY www.walletsmarts.co.uk Tel: 01556 502 381 WALLETS MARTS CASTLE DOUGLAS LTD “The Premier Marketing Centre for South West Scotland’’ Forthcoming Sales of Store Cattle There’re no cattle will ‘shift’ like them MONDAY 11th MARCH SALE OF 500 STORE CATTLE MONDAY 25th MARCH SALE OF 450 STORE CATTLE MONDAY 8th APRIL SALE OF 700 STORE CATTLE MONDAY 22nd APRIL SALE OF 1100 STORE CATTLE DON’T MISS CAREERS SPECIAL JobsInAgriculture.com JobsInAgriculture.com JobsInAgriculture.com March 1, 2024 Twokeyaimsfortheindustryaretohelpthosealreadyin farmingthriveandencouragingnewtalentfromoutsidethe sector.Thisspecialfocusesonleadership,openingdoorsto newfacesandworkingtowardsamoreinclusivefuture. Kaleb Cooper bursary boosts farm careers CAREERS SPECIAL Edited by Emily Ashworth emily.ashworth@agriconnect.com 01772 799 446 In association with By Emily Ashworth L ast year farming cham- pion and TV personality KalebCooperlaunchedhis very own bursary to help youngsters from non-agri- cultural backgrounds get a step up in the industry. In association with the Royal Agri- cultural University (RAU), two lucky students were picked and now get the chance to work alongside the Clarkson’s Farm star on a placement, aswellasreceivinga£3,000bursary. Caitlin Oxton and Caitlyn Bartlett are both from non-farming backgrounds. Caitlin is in her second year at RAU studying applied farm man- agement, while Caitlyn is in her first yearstudyingagriculture. theBotharekeentomaketheirmarkin withindustry,andthereisnodoubtthat supportfromKalebandhisarray ofcontacts,theywilldojustthat. Having built up a good amount of experience over the years, Caitlin recalls that taking the first step was the hardest. Shesays:“Thereareafewobstacles, asyouaregoinginwithnoknowledge, whereas others know what they are doing. It is a bit of a catch-up. “The first step is the hardest, when they are throwing everything at you. But it is all possible with the right peo- plearoundyou.” Both are interested in agron- omy, but they both say that getting experience in other areas, such as livestock,isessential,especiallywhen it comes to learning vital skills, such as tractor driving. Having come into the industry with no prior exposure though, what have theysincelearned? Caitlyn says: “I was surprised – and reassured – to see how many women were in the industry when I first start- ed out working in poultry. In the last couple of years, we have done a lot in termsofwomeninagriculture. “It is not as hard to get into the industry as it was 20 years ago.” Kaleb is from a non-farming back- ground and has somewhat made it his mission to speak up about the variety of careers within the sector. He hopes to give others the chance toexperienceit. Important He says: “Farming is who I am. Encouraging the younger generation into agriculture has always been so important to me. I feel lucky that I knew my path from such an early age and want to help spread that passion and drive. Launching this bursary means so much, as it can support students who want to pursue an agricultural career or who might be struggling to get into farming. “Having come from a non-farming background, I believe agriculture can be for anybody. I know there is so much potential for young people to havebrilliantcareersinagriculture. “It should be open to all and espeCaitlin Oxton Caitlyn Bartlett Profes Instructors Lecturers Employment Gain Hands-on Practical Industry Approved Qualification Scan the QR code to discover the AGCO Academy. p34 35 Mar1 OM MB.indd 2 28/02/2024 12:05 For all the latest career news and advice, please see our Pages 34 - 45 In association with


•
•
•
•
•
•
FAX:
•
•
Everglades Nurseries Ltd

Orders for Insertion of advertisements in Farmers Guardian are accepted subject to the following conditions:
1. Advertisement copy shall be legal, decent, honest and truthful, and shall comply with the British Code of Advertising Practise and all other codes under the general supervision of the Advertising Standards Authority: and shall comply with the requirements of current legislation.
2. While every endeavour will be made to meet the wishes of advertisers, the publisher does not guarantee insertion of any particular advertisement.
3. In the event of any error, misprint or omission in the printing of an advertisement or part of an advertisement the publisher will either reinsert the advertisement or relevant part of the advertisement as the case may be, or make a reasonable adjustment to the cost. No reinsertion, or adjustment will be made where the error, misprint or omission does not materially detract from the advertisement. In no circumstances shall the total liability of the publisher for any error, misprint or omission exceed
a) The amount of a full refund of any price paid to the publisher for the advertisement in connection with which liability arose. OR
b) The cost of a further corrective advertisement of a type and standard reasonably comparable to that in connection with which liability arose.




Chicken
CONCRETE
4. The publisher reserves the right to withdraw, amend or alter any advertisement it considers necessary.
5. Cancellations or advertisements are accepted providing they comply with the cancellation deadlines which are published at regular intervals.
6. Advertisement orders are issued by an advertising agency as a principal and must be on the agencies official form (when copy insutructions not constituting an official order are issued they must be clearly marked at the head “Copy Instructions – not an order”.
7. Advertising Agency commission will only be granted to those Agencies who are currently recognised by the Newspaper Society at the time of placing an advertisement order and copy. The rate of commission is determined by the publisher.
8. When credit is allowed payment is due within 7 days. Monthly accounts are due in full each month. “We reserve the right to charge additional costs and interest for non payment within our credit terms”.
9. Only standard abbreviations are permitted by the publisher. List available on request.
10. Classified display advertisements must be at least 3cms in depth for every column wide, and the minimum size of any advertisement is 2 lines.
11. Every endeavour will be made in order to forward replies to box numbers to the advertisers, as soon as possible after receipt by the publisher, but the publisher accepts no liability in respect of any loss, or damage alleged to have arisen through delay in forwarding or omitting to forward such replies, however caused. Circulars and the like should not be distributed through publisher’s box number facility.
12. The placing of an order for the insertion of an advertisement, is an acceptance of these conditions and any other conditions stated on any type of order form by an agency or advertisers are not applicable if they conflict with any of the above.

New
Second hand tanks currently available:
Mueller 8000ltr,
Packo



Portable Milking Machine
Complete with Honda engine and Electric motor. This unit is ready for work and can be delivered anywhere in the UK.
Livestock Supplies LTD
Ashley: 07831 887531, Office: 01829 260328, Will: 07769 974476 www.livestocksupplies.co.uk
HEAVY
Cookers & Heaters Personal Services Trees & Shrubs Horticulture Fertilisers Milking Equipment Contractors Livestock Services MULLER 16,800L bulk tank, inside or out, single phase, available soonTel: 07970 048328 Wales (P) 57 March 1, 2024 | FGbuyandsell.com J.P WHITTER (WATER WELL ENGINEERS) LTD
BOREHOLE DRILLING FOR DOMESTIC AND COMMERCIAL PURPOSES
WORK CARRIED
STANDARD
OUT TO A VERY HIGH
WATER SYSTEMS INSTALLED
BOREHOLE PUMPING
INSTALLATIONS
24HR BREAKDOWN
SERVICE
FREE QUOTATIONS
VISITS THE POTTERIES GARAGE
LANE, LEIGH, WIGAN, LANCS, WN7
01942 871900.
AND SITE
SMALLBROOK
5PZ. TEL:
01942 896843.
of office: 01942 893660 Visit our Website www.waterwellengineers.co.uk
sally@waterwellengineers.co.uk
Out
Email:
Borehole Drilling
Treatment & Filtration
•
Water testing 01625 878411 www.blairdrilling.co.uk
WELL DRILLING
WATER
Used
&
Bulk Milk Tanks
9000 & 12,000 ltr Fabdec 4000ltr & 6000ltr
RMIB 3800ltr & RMIB 6000 ltr
New Heat Recovery units in stock 01772 780806 www.ddcooling.co.uk
GROOVING
Neil O’Donnell -Tel: 01900 817009 or 07759 194600 Nationwide (T)
DUTY replacement
parlour.
troughs, for any
01260 226261 (T)
West and Midlands areas. Anaerobic digester feed stocks also available. www.billingtonfarms.co.uk t: 07718 617433 e: billingtonfarms@yahoo.com Plain, Cows & Bulls Wanted. Also casualty collection service with veterinary certificates direct to our own abattoir. 24 hours a day 7 days a week collection for emergencies TEXT OR TELEPHONE STEPHEN: 07860 636 605 OFFICE: 01772 626 951 @ETS PHEN TAY ROL BAMBER BRIDGE Lancs, Cumbria, Cheshire. Yorkshire. MARTLANDS COLLECTORS OF DEAD ANIMALS THROUGHOUT LANCASHIRE AND CHESHIRE Competitive prices PLEASE CALL: 01704 893161 or 07768 051800 (24 hrs) Martland’s the name, knackering’s the game Established over 100 years Quickthorn 20/40cm 0.32 (hawthorn) 40/60cm 0.43 40/60cm bushy 0.68 60/90cm 0.59 90/120cm 3ft /4ft bushy 1.41 Blackthorn 40/60cm 0.41 60/90cm 0.53 Beech 40/60cm 0.82 60/90cm 1.19 90/120cm 1.90 Privet 40/60cm 0.60 60/90cm 0.95 Hornbeam 40/60cm 0.55 60/90cm 0.70 90/120cm 1.75 Box 20/30cm 1.28 30/40cm 1.62 English Yew 30/40cm 2.15 Cherry Laurel 40/60cm 1.95 60/90cm 2.45 Rabbit Guards 0.28p Canes 0.12p Trees, Specimen Plants, Hedging, All Sizes Available. A standard delivery charge may be added. Quotes given for Countryside Stewardship Scheme. Ring for native tree whips availability and prices. All Prices Exclude VAT. Prices are subject to change. 269 Southport Road, Ulnes Walton Leyland Lancs PR26 8LQ
muck and pig slurry excellent cheap fertilisers, delivered in artic loads to the North
www.evergladesnurseries.com sales@evergladesnurseries.co.uk Tel: 01257 450533
THE QUICKTHORN NURSERY
Call 01772 799500 and place your ad today Nursery Fresh For Planting Success TOP QUALITY TREES & HEDGING PLANTS Cold stored for freshness Also rabbit guards, canes stakes and ties BURTON ROAD, FINDERN DERBY DE65 6BE Call now for professional adviceQUICKTHORN www.woodgrow.com Tel: (01332) 517600 Woodgrow Horticulture Ltd Growing Since 1973 STRUGGLING TO MEET
you struggling to meet people your age who understand your way of life and who you have chemistry with? If so, it’s time you sought the help of the introduction experts: ‘Friends1st’. Our unique introduction and dating service makes dating so much easier and finding a soul mate possible. We’ve found partners for other farmers and rural members – we can do so for you too. Ring us today 0121 405 0941 to find out more or visit our information only website: www. friends1st.co.uk/christian-farmers-datin Farmers Guardian is the largest multiplatform agricultural information business in the UK 5 year Factory Warranty 100,000 BTU Concept 2 Multi Fuel Cooker Used for central heating, cooking and baking. Runs 20 radiators. Delivered free nationwide. Tel: 0114 257 8891 www.cookersimporteddirect.com FG Buy and Sell 01772 799500
Are

NEW

New

BULK MILK TANKS FOR SALE
from
16,000
15,000
14,000
13,700
10,000
8,000 Ltr Roka Silo
6,750 Ltr Delaval (holds 7,000 Ltrs)
6,000 Ltr Roka
6,000 Ltr Fabdec
5,000 Ltr Packo
5,000 Ltr Mueller Model “O”,
5,000 Ltr Roka
4,000 Ltr Mueller
4,300 Ltr Mueller Model “P”,
2 x Refurbished 1T Ice Builder suitable for 10/12,000 Ltrs every other day
Refurbished 1.3T Ice Builder suitable for 16,000 Ltrs every other day
Refurbished 1.5T Ice Builder suitable for 18/19,000 Ltrs every other day
CUSTOM BUILT HEAT RECOVERY SYSTEMS, TAILORED TO YOUR REQUIREMENTS
Smaller bulk tanks available, emergency open & enclosed, loan tanks available to rent, main dealer for new Ro-ka milk cooling systems.


Calf Hutches. Complete with fencing. A large selection of all animal and calf feeding equipment and all other associated products also available. Massive saving on list price
Livestock Supplies Ltd.
Ashley: 07831 887531 Office: 01829 260328
www.livestocksupplies.co.uk

For further details please call S.W Refrigeration specialising in “On Farm cooling Equipment” 01392 210344 or Paul on 07974 140949



Ashley: 07831 887531, Office: 01829 260328, Will: 07769 974476 www.livestocksupplies.co.uk











FGinsight.com Milking Equipment Pigs PUREBRED LARGE White Boar. 8 months old. Good conformation. £180. Can deliver. Tel D Williams 01352 713644 or 07881 857943 Holywell (P) | March 1, 2024 FGbuyandsell.com 58 FGBuyandSell.com We take a farmer-centric approach to media. Our job is to help farmers run their farms more efficiently and make better purchasing decisions F G B uy and Sell 0 17 72 799 5 00 Livestock Equipment Dairy Cattle MOBILE & GENERAL PURPOSE AUGERS Sales, spares & repairs Tel: 01746 762 777 www.danagri-3s.com BIDLEA HERD Holstein Freisian Bulls For Sale Black & White and some Red & White Plenty to choose from - first come first served! Tel: Ray Brown 01477 532220 or 07885 652718 Cheshire (T) agrisilo.co.uk sales@agrisilo.co.uk KEEPING YOUR FARM GROWING AGRI SILO AUTOMATIC FEEDING SYSTEMS FIBERGLASS FEED SILOS 07903 663715 DAIRY CATTLE FOR SALE A weekly selection of freshly calved & in-calf dairy cattle sourced from the UK. All guaranteed and delivered anywhere in the UK Finance can be arranged. Livestock Supplies Ltd
BRAND NEW & UNUSED Fibreglass CALF -O-TEL
& REFURBISHED
available
500
50,000 Ltrs!
Ltr Roka Silo
- *Special Offer – IN STOCK* 20,000 Ltr Roka *New* - *Special Offer – IN STOCK*
Roka Silos and Tanks
Ltrs to
25,000
*New*
Ltr Delaval
Ltr Fabdec (holds 17,000)
16,000
Ltr
Serap
Ltr Fabdec
Ltr Roka
Ltr Fabdec
Business Use Customers On y Shire Leasing PLC s authorised and regu ated by the Financ al Conduct Author ty BUYING LIVESTOCK? - Free up cash flow - Simple application - No major upfront costs
UK and America.
Please feel free to contact
Richard – 07816 173689
John – 07885 739120
HERD OF CROSS BRED COWS FOR SALE (HOLSTEIN X FLECKVIEH X NORWEGIAN RED)
Closed herd for many years. Low replacement rate, profitable herd. 220+ milkers plus followers.
Tel John 07710 122187 or Stuart 07719 616741 Shrops (P)

FRESH REARING CALVES
Available in suitable batches delivered to most parts of the country
Continental Bull and Heifer calves
3-5 weeks old available now.
Quality store cattle
Five Red and Black Limousin stock bulls
and bulling heifers for sale
Some Semen tested.
From a closed herd. Easy Calving.
TB4 area. Younger bulls also available
Telephone: 01978 780368 or 07986 113221 Wrexham (P)
Tel Edward: 07770 457453 N. Yorkshire (P)
BLINKBONNY ANGUS BULLS
High Health Status
Sired by top AI Angus Bulls, bred for calving ease, high growth & maternal traits. Fully guaranteed & ready to work. Will deliver when required.
Contact Robert Shanks 07974 968150 Kelso (P)
PEDIGREE HEREFORDS
YOUNG BULLS top EBV’s
Choice of 20 from our 180 cow herd
TB4 BVD & Lepto vacc. Call Henry 07866 222062 - details on website www.ribbleaberdeen-angus.co.uk
TREDON LIMOUSINS
PEDIGREE

Bulls and select Females for Sale from a high health herd, with fully registered pedigrees.
Further details can be seen on: www.lowergroveherefords.com
Contact: Paul on 07730095062 or paul@lowergroveherefords.com

HIGH ENERGY FODDER BEET
CLEAN- DESTONED, WASHED, WHOLE OR CHOPPED BEET
AVAILABLE IN 20 & 30 TON LOADS DELIVERED NATIONWIDE
THE VERY BEST QUALITY
TEL: 07584 636338
TOP PEDIGREE REGISTERED HEREFORD BULLS AND HEIFERS. All home bred, quiet to handle. Delivery available. 07885 594143 or 01394 460408 (East Anglia)


BULLS AND HEIFERS FOR SALE
Excellent choice. Great conformation, colour and temperament. Ready to work. High health accredited for IBR, Lepto, BVD and Johnes 1, TB4 North Yorkshire 01756 720210 - 0777 99 20202 More details visit: www.whitehillherefords.co.uk
HAYLAGE for sale
www.haylageforsale. co.uk. Round bales & square bales. Tel: 07785 361396 (T)
ROUND BALE Wheat, Oat and Barley Straw, Tel: 07415 867963 or 07896 712253 Lancs (P)



• office@proforage.co.uk
• 01565 758755 • 07484 364842
R.F FIELDING
Hay & Straw for Sale in all types of Bales. Good quality.
Reasonable prices.
TEL: (01625) 531629 OR (01625) 522249
AK SHARPE & SONS
ALL TYPES OF HAY AND STRAW FOR SALE & WANTED
Competitively Priced
Andrew 07970 052 419
Phillip 07973 208 384 LANCS (T)
LIQUID FEEDS to encourage forage intake. Molasses and molasses blends plus additional minerals if required. J E Morten: 01663 734621 High Peak, Derbyshire (T)
DAIRY, BEEF Nuts & Blends. Fodder beet, Potatoes and Maize Silage now available Tel: 07837 485652 Cheshire (T)
FODDER BEET Clean & stone free. Ray Darley 07860 212800 Nationwide Delivery (T)

FGinsight.com
STRAW, HAY & Haylage Large square bales. Tel: 07785 361396 Bolton / Wigan (P)
Dairy Cattle 59 March 1, 2024 | FGbuyandsell.com Call 01772 799500 and place your ad today Call 01772 799500 and place your advert today Feedstu s & Bedding Beef Cattle Beef Cattle PEDIGREE LIMOUSIN BULLS NO DE-HORNING REQUIRED ALL CALVES WILL BE BORN WITHOUT HORNS THE TREDON HERD - (Limousins) HOMOZYGOUS POLLED CHOICE OF 6 RED OR BLACK • Good conformation & muscling • Exceptional temperament. • High health status. TB4. • Ready For Work • Semen tested Prices start from £3,000 Also available a selection of cows and heifers for sale. Tel: 07849 153733 or 01223 426412 AA ABBERTON ANGUS bulls & heifers,TB1, biobest elite health 15 years accreditation IBR, BVD, Lepto Johnes - Tel: 01386 462534 or 07592 798555 abbertonaberdeenangus.co.uk Richard Tomlinson Top quality hay and straw. All types of big bales and conventional bales. All areas considered. Tel: 07933 783232 Very competitive prices At Your Service Quality Breeding, Hi Health 07891 781542 airedaleangus@outlook.com Adrefelyn Aberdeen Angus Has a selection of working bulls
LIMOUSIN BREEDING BULLS Homo Polled - All calves will be born without Horns. Also Heterozgous Polled. Choice of Red & Black, Choice of 10. Good conformation and temperament. High health status. TB4. Ready For Work Tel: 07849 153733 or 01223 426412 Cambridgeshire (P) 20 BRITISH BLUE X FRIESIAN HEIFERS 8-9 months old TB 4 Area Ideal Suckler Cows Tel: 07748 028448 East Anglia (P)
months.
17-22
PEDIGREE HEREFORDS FOR SALE Bulls ready for work Excellent choice of bulling heifers Elite Status High Health, TB4 North Yorkshire 01756 720210 - 0777 99 20202 www.whitehillherefords.co.uk
sourced directly from Welsh/Shropshire Borders Farms, delivered to your farm. Delivery Nationwide. Livestock Supplies Ltd www.livestocksupplies.co.uk Contact Colin Montgomery 07885515172 Lochwinnoch PA12 4JP accredited. Gilmartin Pedigree Polled Hereford Bulls 3 Well bred, Halter trained Bulls 18 months - 2 years. Vaccinated for BVD + IBR, TB 4 Area John Procter, Waterbeck. Tel: 01461 600257 or 07729 405369 Lockerbie (P) FOR SALE FROM LEESEMANOR BEEF Quality, home-bred Limousin cross British Blue young cows and heifers, with Lim x and BB x calves at foot. Also two excellent Lim x British Blue bulls. Eager for work, all quiet, TB tested and ready to go. ALWAYS NEGATIVE FOR TB Wilf Lomas - 01606 832142 or 07769704628 | June 29, 2018 FGbuyandsell.com 60 p060.indd 60 27/06/2018 13:50:21 Ashley: 07831 887531 Office: 01829 260328 SUNSHINE LICKS We do same day delivery We will respond to your enquiries the same day! We deliver to every area twice a week. SUNSHINE FARM FEEDS BURNLEY www.sunshinefarmfeeds.co.uk Nick Wilkinson Mobile 07952 078732 Growth Promoter Licks Fertility Licks Easy Calving Licks Wormer Licks Coccidiosis Licks Orf & Ring Worm Licks Staggers Licks Pneumonia Licks Easy Lamber Licks Nationwide Delivery any Quantity Design your own Licks or bagged minerals to your own farm and requirements Store Open at Gisburn Auction Mart on Thursday & Saturday Quality Pays Everytime CALL NOW 01949 844700 www.midlandfeeds.co.uk CALL NOW 01949 844700 www.midlandfeeds.co.uk CALL NOW 01949 844700 www.midlandfeeds.co.uk FARM ASSURED MIXED CAKE Chocolate/Sponge Cakes/Doughnuts ME 16.1 - High Starch - High Sugar VERY COMPETITIVE RATE SEAFIELD PEDIGREE ABERDEEN ANGUS BULLS Tel: 077157 64351 Ready to work, delivered direct to your farm, very quiet, easy calving. Also females available. Health monitored, closed herd, full pedigree with each animal, Red tractor. Semen Available. Hay-Straw-Silage-Haylage In All Bale Types Barley-Wheat-Oat-OSR Straw Meadow & Ryegrass Hay Haylage & Silage Clamped Silage- Grass-Maize-Wholecrop Fodder Beet
& Rolled Barley-Wheat-Oats Delivered or collected throughout the uk and Ireland • www.proforage.co.uk
Whole
FODDER BEET
Mixed
Biscon

12% Protein/14 ME) £225 ex store
CALL NOW 01949 844700 www.midlandfeeds.co.uk
Tomlinson Bros
Top Quality
Hay & Straw.
All types of big bales delivered.
01829 782378 or 07710 933681
LOWER YOUR VET BILLS WITH WASHED SILICA SAND CUBICLE BEDDING
* Helps to eradicate mastitis problems and lowers your milk count
* Equestrian sand also available Tel 07730 897138 / 01484 603130






























delivery in the UK with offload included
Apply for an account
Supporting British farmers for over 40 years

CANCELLED



FGinsight.com Feedstu s & Bedding Animal Health
AVAILABLE FREE. Can be collected from our yard. Must have U1 Exemption. Ring Martlands01704 893161 | March 1, 2024 FGbuyandsell.com 60 FGBuyandSell.com
& CO (WESSEX) LTD HAY, STRAW & SHAVINGS BOUGHT AND SOLD trading for 130 years 01285 653738 COSISAN Ultimate Bedding Conditioner Containing a DEFRA APPROVED Disinfectant Drier Beds • Sanitised Beds
HARDCORE
ABBOTT
ORDER
T-wall pipe x 6mtr, perf-plain inc cupler, £13.50 each based of packs of 100, odd lengths £16
packs delivered most area FOC, Tel: Farnells Agri Plastics on
109692 (T)
BARRIERS
poles, Sleepers, Astroturf for
Tracks
fencing. Henmans Tel-
533741 Nationwide Delivery (T)
sales@briarwoodproducts.co.uk
641 446 SUPPLYING EVERYTHING EXCEPT THE FRAME Working direct with British farmers British farming family owned manufacturer 30 year guarantee on all EUROSIX fibre cement sheets Fast 3-5 day
110mm
each,
07850
CRASH
telegraph
Cow
etc, Security
07768
briarwoodproducts.co.uk
01934
CALL NOW 01949 844700 www.midlandfeeds.co.uk
Meal (Approx. 12% Protein /14 ME) £185 ex store
Mixture (Approx. 14% Protein /13 ME) £205 ex store
Blend (Approx. 16% Protein /13 ME) £225 ex store
Pellets (Approx.
Protein /13 ME) £245 ex store NEW STORE IN CUMBRIA One Tonne Bag Collections
Biscon
Cereal
Cereal
Mixed
18%
Pellets (Approx. 18% Protein/13 ME) £275 ex store
Meal (Approx.
IMPORTANT NOTICE TO ADVERTISERS Although every advertisement is carefully checked,occasionally mistakes do occur.We therefore ask advertisers to assist by checking their advertisements carefully and advise us immediately should an error occur. We regret that we cannot accept responsibility for more than ONE INCORRECT insertion and that no re-publication will be granted in the case of typographical or minor changes which do not affect the value of the advertisement. While every endeavour will be made to meet the wishes of the advertisers, the publisher does not guarantee insertion of any particular advert. priced accordingly Tel 07976 103807 jim@beaverfit.com CONCRETE SECONDS PIPES • Quality breathable/water repellent materials to maintain body heat • Strong metal buckles for Longer life • Crossover straps for secure fit • Machine washable Tel +44 (0)1387 750459 E: info@britmilk co uk | W: www britmilk co uk from BRITMILK Calf Jacket Calf Jacket SHEEP ADVERTS For all our sheep adverts, don’t miss our sheep supplementfree inside this week’s Farmers Guardian farmersguardian.com SUPPLEMENT Edited by angela.calvert@agriconnect.com 796 SHEEP GRAZING Making 3 WORMING BESTPRACTICE treatments PERFORMANCE niquesystem 10 TOP Avoiding 12 PEDIGREE value DUTCHSPOTTED mark NEW Lookingto 22 NUTRITION Switch 24 basics &SELL classifieds This sheep supplement includes pedigree and commercial features, as well as advice on improving health and productivity in your flocks.


•
•
•
•
•
•

•
•











Buildings 61 March 1, 2024 | FGbuyandsell.com Call 01772 799500 and place your ad today Reaching deeper and further into UK farming than any other media group Call 01772 799500 and place your advert today Building Materials CUMBRIA STEEL FABRICATIONS LTD T: 01228 711318 M: 07545 070 727 E: OFFICE@CSFAB.CO.UK • Refurbishment of existing Buildings • Storm damage repairs • Erection service • Foundation & groundworks Please contact Neil on 01228 711318 for all Enquires and a no obligation quotation UNIT 7, BRISCO BURN BUSINESS PARK, LONGTOWN, CARLISLE, CUMBRIA CA6 5TR www.csfab.co.uk Suppliers of Agricultural, Equestrian & Industrial Steel Framed Buildings. Office: 01630 409009 Mob: 07498 357997 Email - sales@bridgewater-construction.co.uk www.bridgewater-construction.co.uk Agricultural, Equestrian and Industrial Buildings • Specialists in Steel Framed Buildings • Design, Fabrication & Installation • The best quality materials are used within our manufacturing process for all buildings. t: 01352 719182 f: 01352 837690 e: tracey@jonesbrothersconcrete.co.uk www.jonesbrothersconcretepanels.co.uk Pre-Stressed Concrete Wall Panels Inspired by the latest technology in Pre-stressed Concrete Wall Panels and with the desire
continue
meeting our customers’ requirements regarding Quality, Design, Volume & Delivery
we have opened
improved manufacturing facility
Greenfield,
Wales
to
in
... ...
a new &
in
Flintshire, North
Brand new precision built moulds &
tooling
Larger range of sizes & loadbearing options (95, 145, 200 & new 240, 280mm)
Selection of Concrete Lego
Blocks
Increased capacity
Made to measure
Shorter lead-times
Established Quality Assured CE marked products
Design & Bespoke Project capability Box Profile & Corrugated Steel Roofing Sheets MANUFACTURERS OF STEEL ROOFING SHEETS & FLASHINGS • Box Profile Roof & Wall Sheets • Corrugated Sheets • Anti Condensation Sheets • Fibre Cement • Composite Panels • GRP Rooflights • Flashings • Fixings • Purlins • Nationwide Delivery Call us FREE on 07398 508 780 hello@claddingandconstruction.com www.claddingandconstruction.com INSULATED ROOFING AND SIDE CLADDING SHEETS MANUFACTURED TO YOUR LENGTHS Range of colours, thicknesses, 20mm, 30mm, 40mm, 60mm 80mm + lowest prices. ICP Ltd. Tel: 07702 701776 www.icproducts.co.uk CUMBRIA CONCRETE PRODUCTS LIMITED www.cumbriaconcreteproducts.com HIGH QUALITY PRE-STRESSED CONCRETE PANELS For a competitive price please contact 01228 674 561 or email: carlisle@cumbriaconcreteproducts.com AINSCOUGH METALS 01695 364210 Nationwide Delivery www.ainscoughmetals.co.uk New & Used Steel, Crash Barriers and Roofing Sheets for Sale 2 ½“ x ¼“ flat £0.57/ft 4” x 5/16” flat £1.17/ft 5” x 3/8” flat £1.87/ft 6” x ½ “ flat £2.59/ft 3” tube £0.87/ft 4” tube £1.15/ft PleasevisitourwebsiteforourdailydealsontheFarmersCorner






















FGinsight.com Buildings ONE OF THE UK’s LEADING MANUFACTURERS OF STEEL FRAME BUILDINGS @GrahamHeathConstructionLtd @GrahamHeath Construction @GHConstruction 20 years’ Experience Made in Britain Nationwide Delivery Bespoke Buildings 5* Customer Service www.gh-construction.co.uk 01270 781158 info@gh-construction.co.uk Call us for your free quote & Special Offers. BackingBritishFarming AGRICULTURAL, INDUSTRIAL & EQUESTRIAN BUILDINGS LIVESTOCK SHED OFFER 100’ x 40’ x 15’ + 4ft 6″ Cantilever From £25,500* Including Concrete Panels. * Ex works GRAIN STORE 1,000T 80’ x 60’ x 20’ From £50,000* Including Concrete Panels * Ex. Works Scan for the latest building offers Q ualityAssuredBuildi n g s CAUTION We are currently aware of a number of fraudulent advertisers attempting to sell items within the classified section. Whilst we endeavour to protect our readers and pull these adverts before going to press, sometimes they may unfortunately appear in print. Please be mindful before entering into any deals you PROCEED WITH CAUTION with the seller and do not part with money until goods are received. Farmers Guardian are NOT responsible for any part of the transaction that takes place with the seller and the buyer. Farmers Guardian | March 1, 2024 FGbuyandsell.com 62 01630 655 555 | sales@flgb.co.uk | www.flgb.co.uk • Cubicle Buildings • Lambing Sheds • Dairy Units • Equestrian • Workshops • Grain Stores • Industrial Units • Bespoke Design • Nationwide Coverage We manufacture, supply & build... FGBuyandSell.com





























63 March 1, 2024 | FGbuyandsell.com Call 01772 799500 and place your ad today We know farming. Farmers Guardian brands are embedded in the agricultural community and have a position of authority and trust Browse. Sell. Buy at FGBuyandSell.com A New Route to Market FGBuyandSell Caravans & Log Cabins Caravans & Log Cabins Buildings Tanks SPRAY FOAM INSULATION To Crop & Livestock Stores, Poultry Sheds, Cattle & Pig Buildings, Workshops & Barns. Frost & Condensation Protection. Temperature Control Energy Saving Tel: 01405 812682 www.webstersinsulation.com info@webstersinsulation.com 35f Status Super Static Caravan In good condition, valeted and new carpets fitted. Suitable for on farm accommodation. £5900 ONO. Delivery can be arranged. Tel: 07375 728452 Lancashire (T) eco friendly affordable sustainable materials bespoke design TheNaturalWayToBuild Formoreinformationonallthebuildingspleasevisitourwebsite. Web:www.timberspecs.co.ukEmail:info@timberspecs.com Tel:01580212141Mob:07710480259 Bespoke Design Service AndTechnicalData PaynettsFarm,CranbrookRoad, Goudhurst,Kent,TN171DY Tel:01580212141 Mob:07710480259 Email:info@timberspecs.com Mobilehomes,holidaychalets,loghomes. Allbuilttoyourrequirements,deliveredand erectedanywhere,weofferbuildsinround, 360mm to up log random and cavity square thick.Housessuppliedtomeetbuilding controlregulations. ������������ ����������� ������������� ������������������������������ ���������� ��������������� ������������������� ���������� ����������������� ���������������������� FinanceOptions Tospreadthecostofyourinvestment, wehavepartneredwithiDeal4Finance andTownandCountryFinancetooffera rangeoffinanceoptionstosuityourneeds, includingmortgagesandshorttermloans. ������ � �� �� ����� ������ ���� � co � � cted an thick. Houses ntrol regula ��� mes holida your quire ywhere, w bespok p ke For further details and a no obligation quote, please contact us: 01829 423 123 info@acjackson.co.uk www.acjackson.co.uk SUPPLYING AND ERECTING STEEL FRAMED BUILDINGS FOR OVER 30 YEARS Agricultural buildings Equestrian buildings Industrial buildings Design, fabrication and installation ACJ-FarmersGuardian-70x132.indd 1 26/01/2021 18:39 TRICKETTS LANE, WILLASTON, NANTWICH, CHESHIRE, CW5 6PY OVER 40 YEARS OF EXPERIENCE WORKING NATIONWIDE • STEEL FRAMED BUILDING MANUFACTURERS • INDUSTRIAL & AGRICULTURAL SPECIALIST • KIT FORM • DESIGN & BUILD • REFURBISHMENTS www.sjb-steel.com Diesel, Oil & Water Tanks • Septic Tanks • Diesel Dispensers • Bunded Oil Tanks • Waste Oil Tanks • Water Tanks • Diesel pumps, hoses, filters & nozzles FREE UK Mainland Delivery* TanksForEverything AlwaysBESTprices: 0800 0568 350 www.tanksforeverything.co.uk












FGinsight.com To Be Let ALTON, HAMPSHIRE – 6000 sq ft modern grain store offering approx. 1500 m3 of bulk grain storage. No drying facilities available. Guide Rent: £12,000/ annum + site service charge and insurance contribution. All enquiries to Giles Wheeler-Bennett Ltd – (01489) 896977. (T) | March 1, 2024 FGbuyandsell.com 64 FGBuyandSell.com Equestrian Buildings Call 01772 799500 and place your advert today TRICKETTS LANE, WILLASTON, NANTWICH, CHESHIRE, CW5 6PY OVER 40 YEARS OF EXPERIENCE WORKING NATIONWIDE • STEEL FRAMED BUILDING MANUFACTURERS • INDUSTRIAL & AGRICULTURAL SPECIALIST • KIT FORM • DESIGN & BUILD • REFURBISHMENTS www.sjb-steel.com For further details and a no obligation quote, please contact us: 01829 423 123 info@acjackson.co.uk www.acjackson.co.uk SUPPLYING AND ERECTING STEEL FRAMED BUILDINGS FOR OVER 30 YEARS /acjacksonltd @ACJacksonLtd Equestrian buildings ACJ-BritDressage-135x150.indd 1 27/01/2021 14:02 Advertising opportunities now available in our Published 15 March, 2024 Call to find out more Call 01772 799500 and place your ad today Inthisspecial,wetakealookatthegrantsavailableto farmersandthefrustrationsoveruncertaintyanddelays. GRANTS SPECIAL Edited by Alex Black alex.black@agriconnect.com 01772 799 409 Farmers’ distrust in RPA deepens over SFI delays ByRachaelBrown Keeping up to speed in this shifting landscape of future farming payments is challenge for many farmersandlandowners. The extended timelines issued bytheRuralPaymentsAgency(RPA) andDefratotheSustainableFarming Incentive (SFI) have deepened farm- ers’ distrust – the very thing both oftheseGovernmentbodiesaredesperatelytryingtorestore. This was the message from H&H Land and Estates chartered surv- eyor and environment adviser, Nick Mullins, who criticised the scrapp- ing of the ‘standards’ terminology within SFI and the announcement of further delays. But despite the ongoing problems with SFI, he insisted there were still The start of the ‘controlled roll-out’ for SFI was promised for the end of August, but that has since been postponed to September 18. Sudden changes Mr Mullins said: “These sudden changes in dates and schemes do not help give us confidence in the RPA the exact thing they are trying torestore.Itmakesitverydifficultto provideassurancetoclientsthatthis will not happen again.” Despite this, he said there was one positive to take away, suggesting that theapplicationprocessappearedtobe ‘less onerous’ compared to previous grant applications. But this was with the exception of common land. Struggle “It has long been known the RPA has struggled to map common land on opportunities within the scheme which could appeal to some farmers andMrlandowners. Mullins said: “We prepare for one thing and then it is delayed or does not happen. If you missed it, the RPA cancelled all previous SFI itagreementswithnowarningtoenable toprovideitsnew2023offer. “This has certainly not been the smoothtransitiontheRPAhadhoped for, but the 2023 offer does seem good, with more actions available for applicants to choose, although why it has scrapped the name ‘stand- ards’remainsamystery.” Deadlines and dates have also shifted last minute too. The Mid-Tier deadline was extended by four weeks, a day before the applications had to be submitted, after what were said to have been technical issues with theRPAonlinesystem. its computer systems. In SFI22 it appeared that this had been resolved, butnowtheRPAhasrevertedtopaper applications.Thismeansthatcommon associations will not be able to apply for SFI until later in the year, at least October,ifnotNovember-December.” The RPA hoped to have an online system available in spring 2024, but Mr Mullins said ‘we will have wait and see’, adding that he would continue to help prepare applicationsand‘putpressure’ontheRPA. All these issues aside, Mr Mullins believed SFI could prove a ‘better option’ for some farmers than Countryside Stewardship (CS), with agreementsonlybeingforthreeyears, making it more appealing for tenant farmersinparticular. for“Therestrictionsandrequirements each option are less prescriptive, enabling farmers to deliver the action Theextendedtimelinesissued bytheRuralPaymentsAgency andDefratotheSustainable FarmingIncentivehave deepenedfarmers’distrust. Get your brand seen by decision makers, influencers, farm owners and managers! 01772 799 500 GRANTS SPECIAL

Planning applications on the rise across UK
In the evolving landscape of UK agriculture, the potential for alternative income through renewable energy projects, specifically solar farms and battery energy storage systems on farmland, is becoming increasingly significant. With the rise in demand for clean power, the opportunity for landowners to enhance their income streams is considerable.
However, the journey from initial approach by a solar or battery developer to the successful operation of a renewable energy project is fraught with complexities.




Interest from developers in leasing sites for solar and battery storage projects is at an all-time high. As a result, this brings to the fore the importance of understanding the complex details involved in progressing a scheme to generating rental return.
Therefore, to maximise benefits and mitigate risks, it is crucial landowners navigate these opportunities with a clear understanding of the financial, legal, and technical aspects.
Partner
Landowners should seek a partner with a proven track record, solid financial standing and experience in managing renewable projects.
It is important to establish early in the process if they are operating it themselves, or if they are simply a middleman. The initial negotiations, encapsulating exclusivity, and heads of terms, are pivotal.
This stage lays the foundation and can hugely affect outcomes. Clear definition of project scope, financial terms, and responsibilities is vital and ensures mutual understanding, reducing confusion.
Securing exclusivity protects both parties. It ensures developers are serious about proceeding and provides landowners with assurance against opportunistic land tying.
This important stage also allows for due diligence, ensuring site suitability and developer capability, all crucial for project feasibility.
Early negotiations set the stage for the economic terms of the lease



or purchase, including rental payments, revenue sharing models, and terms of use. Perhaps most importantly, this stage can reveal the intentions and capabilities of the approaching party.
If a developer is not willing to agree to reasonable terms, or fails to demonstrate their ability to proceed with the project (such as showing proof of funding or a track record of completed projects), it may indicate that they are not genuinely committed to the project.
One of the primary considerations for landowners is the impact of projects on their tax liabilities and the structure of their business.
The transition of land use from agriculture to leased to an operator for renewable energy can alter the applicability of various tax reliefs.
Depending on whether the landowner receives the income personally or through a company structure, income from renewable energy projects could be subject to different taxation rates. So, the implications of such projects on capital gains tax, inheritance tax, and the availability of agricultural property relief and business property relief must be thoroughly examined.
In summary, the journey to developing renewable energy projects on farmland is complex, involving critical financial, legal, and technical considerations. Professional advice is vital from the outset.
nFarms & Property nLand 65 March 1, 2024 | FGbuyandsell.com FOR SALE BY PRIVATE TREATY LAND OFF WARRINGTON ROAD (A56), MICKLE TRAFFORD
parcel of agricultural land totalling 29.98 acres (12.13 ha) with road frontage and access on to the A56 (Warrington Road). The land has natural hedge boundaries splitting it into three parcels, with all the fields currently in grass.
land has be carefully farmed over the years and is ready for someone to start using immediately. berrys.uk.com Agriculturally Tied Dwelling The Cheese Press Chadwick Lane, Hartlebury, Kidderminster DY11 7YH Please contact Chris Jones on 01743 267063 or email chris.jones@berrys.uk.com
Detached 5-bedroom property
Subject to Agricultural Occupancy Condition
For sale by private treaty
Set in 1.12 acres with the opportunity to purchase additional garden area
Guide price £585,000 Call 01772 799500 and place your ad today XX | MARCH 1 2024
A
The
•
•
•
•
•
Tim Sedgewick is director of H&H Land & Estates (Durham). Call 01913 708 530, or email tim.sedgewick@hhlandestates.co.uk
right at the
FG B u y and S ell 0177 2 799 5 00
Tim Sedgewick
PROPERTY LANDSCAPE Get it
start for renewables deals

n4 x 4s FGBuyandSell.com





Finance: Terms & Conditions
Farmers Guardian, Fginsight.com and fgbuyandsell.com (hereinafter referred to as ‘Farmers Guardian) may contain advertisements, links to other Internet websites or online and mobile services provided by independent third parties, including websites and telephone contacts of our advertisers and sponsors (what we call “Third Party Sites”), either directly or indirectly. It is your decision whether you purchase or use any third party products or services made available on or via Third Party Sites and you should read below carefully. Our Privacy Policy does not apply to Third Party Sites. In no circumstances do we accept responsibility for your use of Third Party Sites or in respect of any Third Party products. By Third Party Sites we mean websites, online or mobile services provided by third parties, including websites of advertisers and sponsors that may appear in Farmers Guardian. By Third Party Products we mean products or services provided by third parties. Farmers Guardian contains advertising and sponsorship. Advertisers and sponsors are responsible for ensuring that material submitted for inclusion on Farmers Guardian complies with international and national law. Farmers Guardian (nor its websites) is not responsible for any error or inaccuracy in advertising or sponsorship material. Any agreements, transactions or other arrangements made between you and any third party named in, on (or linked to from) in Farmers Guardian and its websites are at your own responsibility and entered into at your own risk. Farmers Guardian promises to develop and operate with reasonable skill and care and will use reasonable efforts to promptly remedy any faults of which it is aware. Farmers Guardian does not provide any other promises or warranties about its products and services. Farmers Guardian is provided on an “as is” and “as available” basis. This means that Farmers Guardian does not make any promises in respect of Farmers Guardian or the services and functions available on or through Farmers Guardian, Fginsight.com and fgbuyandsell.com or of the quality, completeness or accuracy of the information published on or linked to from Farmers Guardian, Fginsight.com and fgbuyandsell.com other than as expressly stated above. The above disclaimers apply equally to your use of Farmers Guardian, Fginsight.com and fgbuyandsell.com without limiting the above; Farmers Guardian and its websites are not liable for matters beyond its reasonable control. Farmers Guardian does not control third party communications networks (including your internet service provider), the internet, acts of god or the acts of third parties. Farmers Guardian liability will not be limited in the case of death or personal injury directly caused by Farmers Guardian negligence in those countries where it is unlawful for Farmers Guardian to seek to exclude such liability. Any individual, who is in doubt about entering into a loan agreement, should seek professional advice or consult an authorised person who can assist in relation to entering into a credit agreement. Before acting on any information you should consider the appropriateness of the information having regard to these matters, any relevant offer document and in particular, you should seek independent financial advice. All loans, loan participations and financial products or instrument transactions involve risks, which include (among others) the risk of adverse or unanticipated market, financial or political developments and,

in international transactions, currency risk. Lending against non-traditional physical collateral exposes investors to specific risks such as the potential for fraud, theft, damage and illiquidity. Farmers Guardian nAdvice /Consultancy nFinance A T e l e p h o ne : 016 25 8 9 0 00 0 E m a i l : m i ch a e l @ a r c a d ia n e s ta t e s . c o m www.arcadianestates.co.uk DO YOU HAVE LAND? Sites of 1- 1000 acres required for residential development. If you think that your land has potential for development, or you have been approached by a developer, then you will need expert advice that is not available at traditional sources. Michael Rutherford is a specialist agent acting and negotiating for landowners. Contact me for a confidential and expert consultation at no cost. All areas of the UK covered. BPS DELINKED PAYMENT REFERENCE AMOUNTS FOR SALE 01392 833828 BASIC PAYMENT ENTITLEMENTS TO BUY AND SELL Leasing & Hosting Contracts for surplus Entitlements - No upfront payments required Surveyors Ltd If it can be done - we can help - call to discuss: 0800 280 06 05 www.brilliant-finance.co.uk We can quickly arrange loans 3 months - 25 years £10,000 - £5,000,000. Competitive rates for Farm Finance Immediate decision in principle - use for any purpose: Consolidation, Tax bills, Crops, Expansion, New equipment, Livestock etc. Specialist help for Financial Problem Cases Including adverse credit. We can lend against property Farms, Farm Buildings, Farm Equipment & Machinery Equestrian Buildings, Shops, Bare Land and Buy-to-Lets. Bank Said NO? We Usually Say YES! FARM LOANS & RE-MORTGAGES We are a broker not a lender 2015 Isuzu D-Max Yukon 4 X 4 Pickup 1 Owner, 2.5 Twin Turbo Diesel Engine 161 BHP, Six Speed Manual Gearbox, 4 X 4 with Hi-Low Range, Pneumatic Lift Up Lid, Load Liner, MOT £9950 +vat Telephone: 07979 595061 2023 23 LAND ROVER DISCOVERY SE DYNAMIC 7 SEATS PAN ROOF, ELEC T BAR, BLUE 6200 MILES. 2019 69 NISSAN NEVARA TEKNA MANUAL, PICK UP, LOW MILES NISSAN WARRANTY DEC OUTSTANDING CONDITION 2018 18 TOYOTA HILUX INVINCIBLE MANUAL, BLACK, HIGH MOTORWAY MILES, TIDY £14,950 2017 17 TOYOTA HILUX INVINCIBLE MANUAL, METALLIC BLUE ALLOY LINER, LOW MILES, OUTSTANDING 2011 SUZUKI JIMMY 4WD, SWB, PETROL 11 MONTHS MOT. £4,500 2004 SUZUKI JIMMY 4WD, SWB, PETROL ON RETENTION, GOOD RUNNER, TIDY, IN SHORTLY IFOR WILLIAMS TA510 CATTLE TRAILER C/W CATTLE DIVISION, FULL IFOR SERVICE, OUTSTANDING CALL COLIN 07976 252191 DEANFIELD TEST CENTRE BNG & NN National Sale Informal Tender 8th March 2024 Vendors Register your entry Purchasers Request a Tender Form & Lot Register bng@townsendchartered surveyors.co.uk 01392 823935
FGinsight.com
nBPS Entitlements, BNG, NN, Carbon & Water | March 1, 2024 FGbuyandsell.com 66
















67 March 1, 2024 | FGbuyandsell.com Call 01772 799500 and place your ad today Muck & Slurry ATVs For more information contact your local Storth representative 2016 Polaris Sportsman 4x4 570 EFI - Combat Green400 hours - 6700 MilesGood Condition - New Tyres £3950+vat Tel: - 07785 361396 Wigan / Bolton (P) SHEEP SNACKERS Ground drive sheep feeders, all types of atv trailers single and tandem axle, Delivery anywhere Rob Astley trailers ltd Tel 01938 810393 (T) YOUR DEPENDABLE PARTNER FOR SLURRY STORAGE SOLUTIONS enquiries@enviroseal.co.uk t: 01695 228626 www.enviroseal.co.uk SLURRY LAGOON FLOATING COVERS Keeps rainwater out of slurry Reduces odour from lagoons Covers comply with EA and SSAFO legislation SLURRY LAGOON LINERS Comprehensive 25 year warranty Materials meet EA and SEPA requirements Installed and tested by certified technicians Enviroseal provide a complete range of products for slurry storage ‘HOT & COLD PRESSURE WASHERS & AIR COMPRESSORS’ Professional Cold Water Pressure Washers, Hot Water Pressure Washers, Electric Pressure Washers, Petrol Pressure Washer or Diesel Pressure Washers, you’ll be sure to find the best deals here and we won’t be beaten on price! W. Bateman & Co. GARSTANG ROAD, BARTON, PRESTON, LANCS TEL: (01772) 862948 FAX: (01772) 861639 www.bateman-sellarc.co.uk












These axle and transmission brands are commonly found on:

T: 01452 733106 E: ag@grouphes.com
W: tractec.grouphes.com



MASSEY FERGUSON
Replacement tractor parts
Direct to your door Phone for best quotes
Mobile: 07971 243668 or 01545 570 810
CLAAS John Deere, and other makes, combine harvester 2nd hand and new spares. www.jmtcombinehire.co.uk. Tel: JMT Engineering 01926 614345 (T)
BREAKING MASSEY
699, 575, 3070, 3080, 3095, 2645, 6140, 3680 & 8120 Also tractors wanted for breaking Tel: 07710 153603
W.Yorks masseyfergusontractorbreakers.co.uk
Generators, Pressure Washers & Pumps
PTO & Diesel Generator Specialist. Quality new & used. Est 25 yrs. JSPUK
























We take a farmer-centric approach to media.
01772 653569













Our job is to help farmers run their farms more efficiently and make better purchasing decisions FG

FGinsight.com
Generators, Pressure Washers & Pumps
| March 1, 2024 FGbuyandsell.com 68 FGBuyandSell.com
Parts & Servicing
GENERATORS PTO & DIESEL SALE’S, HIRE
COWELL
SONS
& REPAIRS. LARGE STOCK P
&
LTD. Tel: 01432 353050 (T) F.G. ROWLAND LTD Clitheroe Lancashire Tractor Hire & Sales New Tractor & Handle Spares for all Makes New Michelin & Kleber Tyres most sizes in stock Tel 01254 826295 www.rowlandtractors.co.uk Available toHire and Buy Hot and Cold P.T.O. Pressure 3000 p.s.i.16-30L/min 2ndLance Available Fully TractorPowered Hot&Cold Water Pressure Washers www.LandyPressureWashers.com Tel: 01756 794291 Skipton. N.Yorkshire Find us landywashers SPECIALISTS IN AGRICULTURAL PUMPING T. 01777 871100 | W. whisperpumps.com | E. sales@whisperpumps.com MULTI USE SUBMERSIBLE PUMP SLURRY / EFFLUENT PUMP HEAVY DUTY SEWAGE PUMP HIGH VOLUME WASHDOWN PUMP £695 £175 FROM £375 FROM £695 * Prices shown exclude VAT * BRAND NEW UNUSED DIESEL GENERATORS FOR SALE T: 01254 476679, 07595 116 466 or 07783 222 309 COLLECT SAME DAY! NATIONWIDE DELIVERY AVAILABLE www.affordablegenerators.co.uk THE BIG ONE AG275-275KVA 100KVA 150KVA 175KVA 70KVA 80KVA 50KVA 60KVA £19,995 +VAT FULL STOCK OF PARTS AVAILABLE AG50E - 50 KVA £4,750 +VAT AG60E - 60 KVA £5,250 +VAT AG70E - 70 KVA £5,495 +VAT AG80E - 80 KVA £5,995 +VA AG100 - 100 KVA £7,995 +VAT AG150 - 150 KVA £10,995 +VAT AG175 - 175 KVA £12,995 +VAT AG275 - 275 KVA £19,995 +VAT









48 V FORK LIFTS with side shift 3 m mast two ton lift ,two speed transmission , silent clean running 8 hours constant work time on a single charge 48v/360ah heavy duty batteries quick charge supplied .One year parts warranty smart nippy little things, in stock ready to go £9,995 +vat


Here is our new They are available as Euro 3 standard, and have a 4.5m lift height with side shift. Full EU approval on solid of pneumatic tyres. A full backup service is available and, as standard, the forklift will







Full parts back up service available £15,995 + VAT


69 March 1, 2024 | FGbuyandsell.com Call 01772 799500 and place your ad today www.nnvs.co.uk Ivan: 01263 861197 07810 561230 2024 BRAND NEW HZM 8018 1.8 ton Cabbed Diggers hyd quick hitch slewing front arm, heated cab, rubber track, 3 buckets, 3 cylinder Kubota engine, piped for hammer excellent value and in stock ready to go, finance available £13,995 + VAT 2024 BRAND NEW 810BT 3.5 METRE LIFT XINCHAI (perkins copy) engine 48hp electronic shuttle torque converter two speed permanent four wheel drive, hyd quick release head stock available with floatation tyres. £16,500+vat fixed arm £13,995+vat 2024 VSM 800 KG MICRO/MINI DIGGER 780/900mm Wide, Koop Euro 5 Engine, Manual quick hitch, comes with 3 buckets as standard £4,950+vat £4,500+vat 2024 VSM 1.2 EXCAVATOR WITH SLEW Back in stock. 3 cylinder Kubota pumps, expanding tracks 3 buckets, unbelievable value £9,495 + VAT InStock Rhino Excavators - Simplicity at its best Parts warehouse on site. One years parts warranty on all machines. Next day delivery available on most machinesThis is a small selection of our stock, please see website for full range 2024 TWO TON BRAND NEW EXCAVATORS Cheapest in the country, one off price, Yanmar engines, full spec, supplied with 3 buckets finance available subject to status
engine
Yanmar
£15,995+vat Kubota £14,995+vat
TRACKED
BARROWS 400kg £2,250 + VAT 600kg hi-tip £5,650 + VAT 1000 kg hi-tip £7,995 + VAT Electric power barrow £1450 + VAT
2021
POWER
7 TON
ultimate solution for your heavy lifting needs. With dual front wheels and a wide head carriage fork positioning, these forklifts offer exceptional stability and manoeuvrability, allowing you to handle even the most challenging loads with ease. Lift Height 4.5 Metres Max Lift Capacity 7000kg £29,995 +VAT
2024
FORKLIFT, The
1300
ride on vibrating
superb creep control and excellent build quality with one years full parts only warranty in stock and ready to go £9,950 + VAT £8,995 + VAT ST200 2 TON Model also available £12,495 PLUS VAT £11,250 PLUS VAT NoVAT
2022
MODEL VSM
kg double drum
roller KUBOTA TWIN CYLINDER diesel
NEW
TOPSENSE
2024
IN BRAND NEW
2024 VSM GOODSENSE THREE TONNE DIESEL FORKLIFTS.
be
the last ten years and are
£13,995 + vat, Euro 5 £15,995 +
7
come with one years parts only warranty. They have proven to
very reliable over
only
vat
Tonne £29,995+vat
2024 GOODSENSE three ton rough terrain forklifts 4.5 metre lift height, Isuzu copy engine. machine weighs 5.4 ton 14_17.5 lug tyres excellent off road capability tried
and tested £19,450 PLUS VAT one years parts warranty
2024 HZM 825 T TELESCOPIC ARTIC STEER 2.5 TON LOADERS 100hp four cyl turbo quick hitch 4.5m level bucket height diesel aux cab heaters full vision cab two speed torque converter, 3.5m front reach comes with bucket & pallet forks £29,500 + VAT £28,000 + VAT OPTION CUMMINS ENIGNE, High speed road gear £32,500 + VAT, £30,000 + VAT 1.6T £21,995 + VAT
2024 HZM 45/17 mini jcb 3cx very versatile machine, comes with standard front bucket, waste grab bucket and pallet forks, rear arm on 40 mm pins and piped with twin line aux hyd £21,995 plus vat
2019 Peugeot 3.5 ton with Equitrek 2 horse body and storage area horse box from new which has only covered 15000 miles with full history very clean and tidy damage free truck £34,000
2012 Vauxhall Chevel 3.5 ton 2 horse w. basic overnight accommodation sink/grill storage and sleeping area. Elec/hook up sockets, tow bar, good solid straight little lorry, 950kg payload, fresh mot and full valet £18,000 no vat
2024 HZM 916 1.6 TONNE LOADER Xinchai Engine, Hydraulic Quick Hitch, supplied with bucket and pallet forks, 1 year parts warranty.


New NH T7.210RC
165HP+ 50K F/Links Exhaust & Air Brakes F/Axle & Cab Susp 650 Tyres POA
0% Finance 3+33 Months T&C’s Apply.


New NH BOOMER 25 Compact Tractor 25HP 2 Speed Hydrostatic 4WD Rear PTO & Linkage ROPS Frame POA
0% Finance 3+33 Months T&C’s Apply




NEW NEW HOLLAND
T6.160DCT 130HP-160HP
6 Cyl 24x24

Rubber Tracks Q/H Piped 3 Buckets POA















NEW JARMET CROP SPRAYERS, 400, 600, 800 & 1000 LITRES AVAILABLE, CHOICE OF





GOOD RANGE OF MORE NEW / USED ITEMS IN STOCK
QUALITY REPLACEMENT PARTS BY &

• TELEPHONE

























Tractors & Equipment 71 March 1, 2024 | FGbuyandsell.com Call 01772 799500 and place your ad today RICHARD ECCLES. 07977 932948 ED TINKER. 07977 932950 STEVE BENNETT. 07770 890760 JOHN CRAIG 07971 599185 Townson Tractors Ltd, West End, Hellifield, North Yorkshire, BD23 4HE Please see website www.townsontractors.co.uk for full details Telephone: 01729 850374 Email: sales@townsontractors.co.uk New & Used Tractors, Telescopic Handlers, Machinery & Equipment 2016 FENDT 718 VARIO 2490Hrs 180HP 53K Air Brakes F/Links FENDT P/Loader 710 Tyres Excellent POA 2016 POTTINGER 6510 TORRO COMBI-LINE Auto-Cut 710 Tyres Steering Rear Axle Low Load Count OBOC POA 2019 JD 6115RC 2230Hrs 115HP Command Quad Plus 40K Air Brakes TLS QUICKI Q4 P/Loader Excellent POA JCB 403 AGRI-PLUS 50HP 2 Speed Hydrostatic Full Cab Heater Road Lights LED Work Lights EURO POA. 0% Retail Finance T&C’s Apply New NH DURADISC 280 Plain Disc Mower POA 0% Finance T&C’s Apply 2012 JCB 8025ZTS 2300Hrs
40K Air Con & Seat 4 Valves Cab Susp LED POA
Retail Finance
Months T&C’s Apply. ERIC TOWNEND
0%
3+33
LOCKWOODS FARM, SCAPEGOAT HILL, HUDDERSFIELD, HD7 4PE
www.erictownend.co.uk
BOOM SIZES, VARIOUS OPTIONS AVAILABLE FROM £1450 + VAT NEW JARMET GRASS HARROWS AVAILABLE IN 4, 5 & 6 METER WIDTHS FROM £1240 + VAT NEW JARMET HYBRID GRASS HARROWS AVAILABLE IN 4 & 6 METER WIDTHS PRICES FROM £2500 + VAT ALL MAJOR REPLACEMENT PARTS FOR MACHINERY AND TRACTORS AVAILABLE, ROCK OIL AUTHORISED DISTRIBUTORS, ALL GENUINE MCHALE PARTS AVAILABLE NEW WATSON REAR HYDRAULIC, END TOW, TRIPLE FLAT & TRIPLE CAMBRIDGE ROLLERS IN STOCK 2022 FUSION 3 21000 BALES, 1000RPM, CAM LESS PICKUP REEL, IMMACULATE CONDITION £52500 + VAT 2021 BAILEY 26’ BALE TRAILER AS NEW CONDITION £9500+VAT Published March 22, 2024 Advertising opportunities now available in our next Get your brand seen by decision makers, influencers, farm owners and managers! Speak to Eva Bailey today 01772 799 500 | fgclassified@farmersguardian.com MACHINERY AND TRACTOR SUPPLEMENT
























































30028080





























FGinsight.com Tractors & Equipment | March 1, 2024 FGbuyandsell.com 72 FGBuyandSell.com NEW ALPLER GSR8 8 Ton Fertilizer & Lime Spreader c.w Stainless Steel Body and Cover £18,000.00 Lely Hibiscus 1515CD Profi. 4 Rotor Rake ................................ £12,500.00 Kuhn AXIS 30.1 Twin Disc Fertilizer Spinner c.w Cover Border Limiter Very Tidy £3000.00 NEW 22FT JMP LIVESTOCK TRAILER .................£15,000 24ft JPM £16,000 26ft JPM £17,000 NEW JPM 22ft 19 Ton Tandem Axle Plant Trailer £10,000.00 NEW JPM 24ft 19 Ton Tandem Axle Plant Trailer .. £10,500.00 NEW Fleming ST2500.00 Gal Vaci Tank on 28.1 x R26 10 stud Axle, 1 Only at .............. £16,500.00 NEW JPM 16 & 18ton Silage Trailer in Stock c.w 10 Stud Have Duty Commercial Axle Air Brakes with Load Sensing Valve, Hyd Back Door, Grain Chute, Sprung Draw Bar, 560/60/22.5 Wheels 16 Ton £22,000.00 18 Ton. £23,000.00 New Alpler GSR5. 5 Ton Lime Spreader (Transpread) c.w Cover...........£14,000.00 NEW Portequip Road legal Sheep Dipper £22,000.00 Shelbourne 19 Twin Auger Tub Mixer. Good Condition. £8,500.00 New Portaquip Twin Axle Bale Trailers c.w Galv Angled Hay Racks, Chequer Plate Floor, LED Lights, Beacon & Tool Box. 27ft on Super Singles £9500.00 New Ktwo Rear End Discharge Spreader. Ring for details & Prices Part Ex Welcome Ktwo Duo 1000 MK11 10 ton Rear Discharge Spreader c.w Slurry Door + Extension £11,000.00 NEW Graham Edwards 20ft Twin Axle Livestock Trailer c.w Decks ............£14,000.00 Power Decks £16,000.00 New Alpler GSR4. 4 Ton Lime Spreader (Transpread) c.w Cover £13,000.00 Samson FLEX 111. 16 Ton Rear Discharge Spreader ............................ £10,000.00 New Portaquip
Galv Angled Hay Racks, Chequer Plate Floor, LED Lights, Beacon & Tool Box. 23ft on 12.5 1 only £7500.00 For more info call Colin Blood on 07800 885075 or head office on 01623 847171 FINANCE IS AVAILABLE ON MOST STOCK! CALL HANNAH ON 07500 786743 FOR MORE INFO
Twin Axle Bale Trailers c.w
8S265 1700 Hrs, Exclusive Spec, Trimble GPS System, Front Linkage, 50KPH, E-Power Transmission, Wheel Weights, Balance of Warranty.
2021 MF
7726 4636Hrs, Exclusive Spec, Dyna-6, 50KPH, Front & Cab Suspension, Front Linkage, Auto Guide 3000, 4 Rear Spools & 1 Front. 40027184 £112,000 D 10027740 £63,000 W 30028138 £103,500 F
MF 7626 5151 Hrs, 600/60R30 Fronts 45%, 710/60R42 40%. 10026911 £55,000 w Manitiou MLT 741-140 V+, 2021, 2002 Hrs, 7 Meter Reach, 4 Tonne Lift Capacity, Vario Transmission. 10028150 £73,000 W Manitou MLT 630-105 5886 Hrs, 2021, Elite Spec, 2019 Model, 2021 Registered, 460/70R24 Tyres. 10028082 £53,000 W Manitou MLT 630-105 Elite Spec, 4323 Hrs, 2018, JSM Joystick, Auto Air-Con, Air Seat, Pick up Hitch, Boom Suspension, Semi Auto Steering Alignment.
£47,500 F
2016 MF
2014
30026870
1838 Hrs, 57KPH, Valtra Submeter Autosteer Guidance, 4 Valve Package & Power Beyond, Front Linkage, Electric & Heated Mirrors.
2020 Valtra T234D
2600 Hrs, 50KPH, Front & Cab Suspension, Loader Ready, ABS Socket, 3 Rear Spools, Front & Cab Suspension, Active Spec. 10027476 £67,000 W
2020 Valtra N154A
2150 Hrs, 57KPH, Power Shift Transmission, 5 Electric Spools, Power Beyond, Trimble Submeter Guidance, EVO Seat, ISOBUS.
2018 Valtra T254V
£88,000 W
5333 Hrs, Profi Plus, 60KPH, Comfort Front Linkage, Hyrdaulic Top Link, RTK Trimble, Section Control, LED Lights. 10026038 £POA W
2020 Fendt 828





























2011,



2019,



2020,

2021,



2018,

nTractors & Equipment 73 March 1, 2024 | FGbuyandsell.com Call 01772 799500 and place your ad today Other products Buckets, Buck Rakes, Grain pushers, Muck Forks, Grabs, Livestock handing systems, Silage rakes Visit our online store to order or call 07912 970066 Please call our used sales team on 01704 468009
REDROCK 16T DUMP TRAILER
Axles, Air Brakes, Magic Door, 385/65R22.5, £19,850 + VAT NEW DALBO TRIMAX 300 LED Lighting, 275mm Tine Spacing, Coupling CAT 2&3, £12,900 + VAT
MASCHIO TIGRE 280 REAR FLAIL TOPPER 540rpm, , 6 Spline PTO, Hyd Offset, £6,750 + VAT
MASCHIO GIRAFFA XL 210SE 540rpm, 4 belts, 810kg, 212cm working width, £9,250 + VAT
SIP 775/6 TEDDER 6 rotor, 1170 kg, Lights, 1.7m rotor diameter, Anti wrap shields, 3yr warranty, £12,700 + VAT
SIP STAR 850/26T RAKE
swath, 2100kg, , hyd rotor lift, wide angle pto, 3yr warranty, £25,250 + VAT
NEW
Fixed
NEW
NEW
NEW
NEW
1.15-2.13m
CLAAS ARION 630
6300 Hours, Full Suspension, F/Links, £38,500 + VAT
603R LOADER
530 Hours, PowrQuad, 40kph, Warranty Remaining, £82,250 + VAT.
JOHN
DEERE 6100M +
2023,
JOHN
DEERE 6130R
1250 Hours, AutoPowr, 50kph, F/Links, £87,000 + VAT
JOHN
DEERE 6155R
3682 Hours, DirectDrive, 50kph, F/Links, 650/540 £77,500 + VAT
JOHN
DEERE 6155R
2136 Hours,
AT
50kph,
PTO,
+ VAT
Autopowr,
Ready,
F/Linkage
£125,000
JOHN
DEERE 6195R
5857 Hours, AP,
50k, Air, AT Ready & Act.
+ VAT
F/Linkage PTO,
£78,500




















KRONE BIG X 770 FORAGE HARVESTER
C/W Easy Collect 903 12 Row Header 2016, 1422 engine hours, 1215 drum hours, 1079 header hours
KRONE BIG PACK 1270 WITH MULTI-BALE SYSTEM INCL. double knotter (up to 9 Bales in 1) bale size - 120 cm wide x 70 cm high, with length of 100 cm to 270 cm, 2022 Ex Demo

FGinsight.com | March 1, 2024 FGbuyandsell.com 74 FGBuyandSell.com STARTIN TRACTORS LTD TWYCROSS CV9 3PW Tel: 01827 880088 Email: sales@startintractors.co.uk *Finance offered subject to Terms and Conditions.
JCB 50 Z- 2 C/W Quick Hitch and 1 x 3’ Bucket 2021, 571 hours
18-Z1, ADJUSTABLE
and
742
JCB
TRACK WIDTH c/w 3 buckets back fill blade
pipe work 2019,
hours
NEW AMAZONE ZAV 2600 Easy Set terminal v3 Disc Roll over cover RH Limiter
NEW AMAZONE ZAV 3200 Profis Tronic Isobus
NEW
SPEARHEAD
TWIGA T65 Mid 85HP Mini Pilot Control Oil Cooler 1.5m Head Hydraulic Roller
SPEARHEAD
NEW
MULTICUT 480 PROLINE FLEXWING 6 BLADE MOWER 2024
ISUZU DMAX UTAH DOUBLE cab, 2019, 44129 miles, rear canopy. £24,995 NO VAT.
UTAH DOUBLE
4x4. 2016,
miles. £12,995 + VAT
ISUZU DMAX 2.5TD
CAB
80100
in
Metallic,
+ VAT
NEW
ISUZU DMAX V-CROSS Automatic
Grey
good spec. £37,599
UTILITY
FROM £28100 + VAT
NEW ISUZU DMAX
single cab 4x4.
KUBOTA U55L4 EXCAVATOR with quick hitch 2019, 1393 hours
JCB JS131 LC C/W 6’ Buckets quick hitch Air conditioned 2017, 4376 hours
NEW KRONE F 320 CV Pull Type Front Disc Mower Conditioner
NEW KRONE EASYCUT R320 CV Rear Disc Mower RH Swath Plate 2024
JCB 2CX STREETMASTER DIGGER / LOADER, 2015, 4800 hours, rear bucket & breaker
CASEIH FARMALL 95A PowerShuttle + LRZ100 loader, 2015, 1600 hours.
TEAGLE DUAL 280 front or rear mount flail mower, roller, 2022.
AMAZONE ZATS 3200 Super Hydro Profis fert spreader, 2019, lots of spec.

75 March 1, 2024 | FGbuyandsell.com Call 01772 799500 and place your ad today






















































































































































































































































































































































































































































































































































